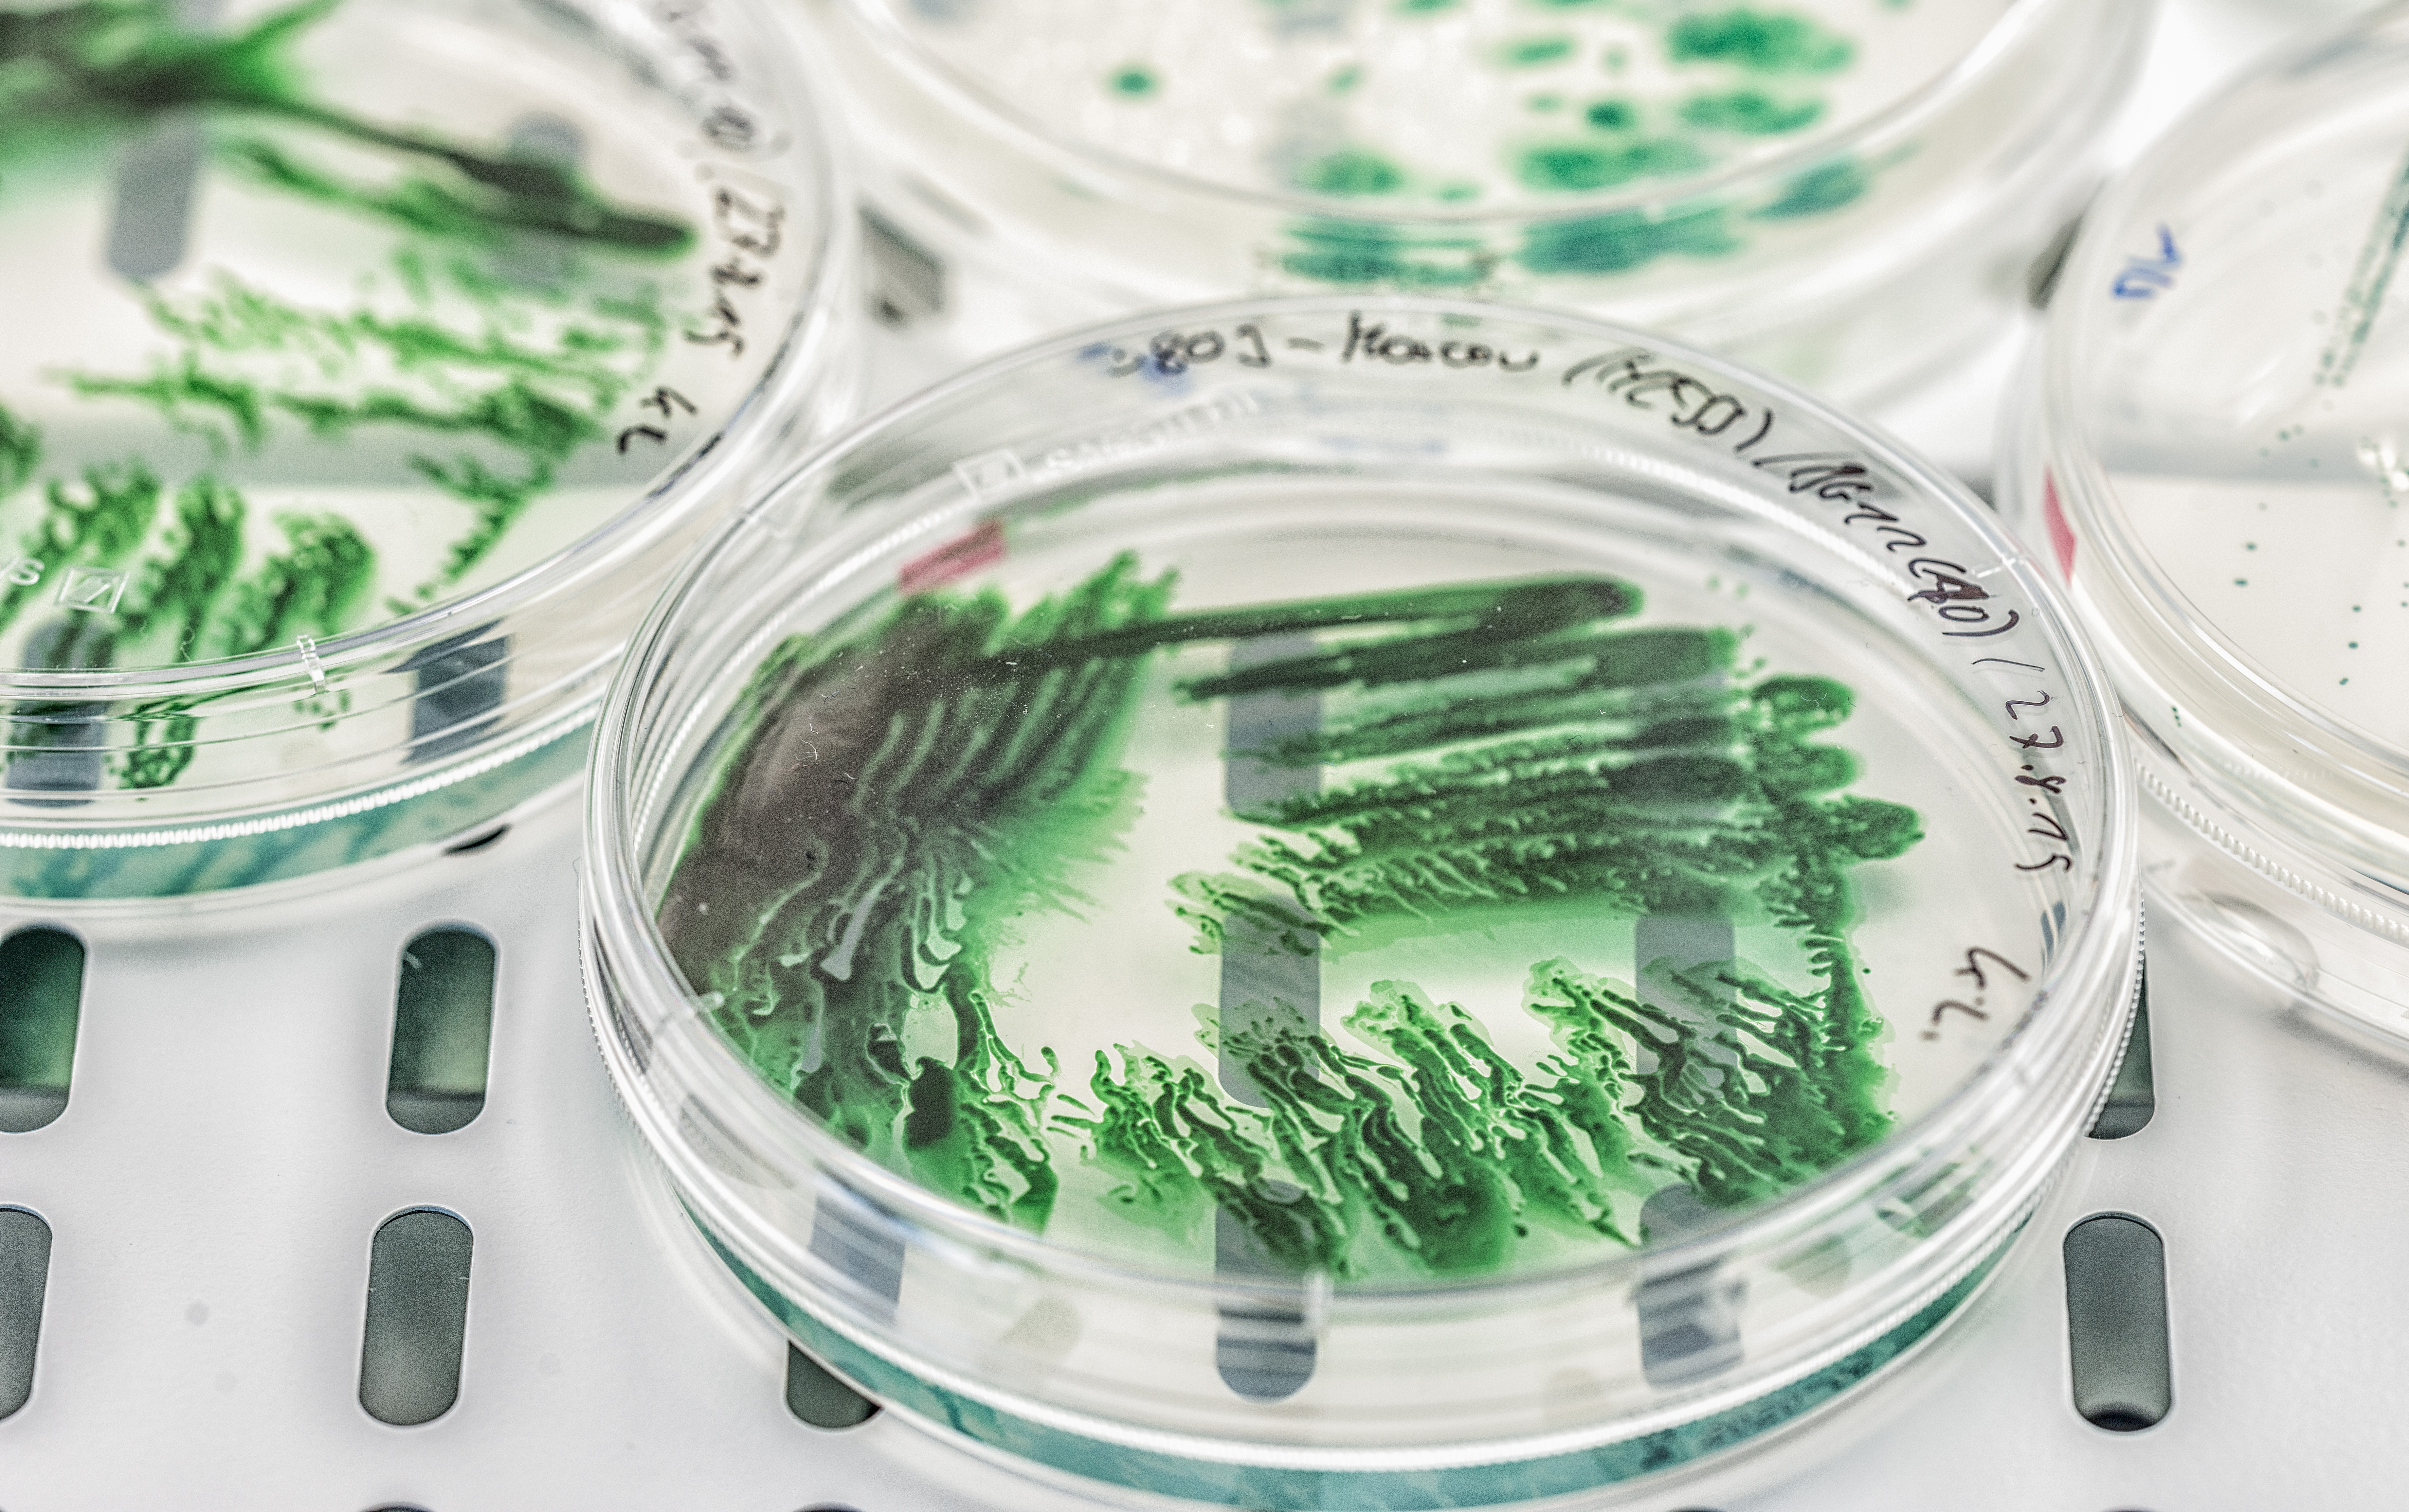

Transfer-News – Archiv
2023

|
Wissenschaft trifft Wirtschaft auf dem EcoInnovate Summit Am 2. November 2023 veranstaltete das UFZ gemeinsam mit der „HHL DIGITAL SPACE – The Digital Transformation Platform“ den EcoInnovate Summit mit dem Ziel, Wissenschaft und Wirtschaft zusammenzubringen. |

|
Zeolithe zur Reinigung von kontaminiertem Grundwasser Die Entwicklung eines vor Ort regenerierbaren Adsorptionsmittel-Festbetts hat einen wichtigen Schritt auf dem Weg zum Markt gemacht. Das Ziel: Chlorierte Kohlenwasserstoffe (CKW) aus kontaminiertem Grundwasser entfernen. |

|
UFZ-Forschung: Fassadenbegrünung in Großstädten Die vertikale Begrünung ist ein innovativer Weg, Großstädte nachhaltiger zu gestalten. Dennoch wird sie eher selten eingesetzt. Ein UFZ-Forschungsteam konnte 24 Barrieren aufzeigen, die einer vertikalen Begrünung im Weg stehen. |

|
Spannende Studie zur Verwertung von Grauwasser Die Studie untersucht die Implementierung einer multifunktionalen, natur-basierten Lösung (NBS) für die dezentrale Grauwasseraufbereitung und Wiederverwendung in Städten. |

|
Herstellung nachhaltiger Flugkraftstoffe – Der neue UFZ-Ansatz Neue Ergebnisse bei Suche nach umweltfreundlicheren und nachhaltigeren Alternativen im Luftverkehr. Ein neues Forschungsprojekt hat gezeigt: Es ist möglich, alternative Flugkraftstoffe aus Biomasse zu gewinnen. |

|
Summer School - Circular Economy & Entrepreneurship Im September organisierte das Team vom HoMe Gründerservice Merseburg und das UFZ StartUp Office ein vielfältiges Programm im Rahmen der Summer School zum Thema Kreislaufwirtschaft und Entrepreneurship. |

|
Projekt zur Herstellung von biobasiertem Nylon gestartet Im Projekt LigNylon arbeiten Wissenschaftler:innen des UFZ und der Universität Leipzig sowie der Partner DOMO Caproleuna GmbH aus der Wirtschaft zusammen, um mit Hilfe von Elektronen und Mikroben „grünes“ Nylon herzustellen. |

|
Dr. Flávio Baleeiro hat den Helmholtz-Promotionspreis erhalten Jedes Jahr werden in der Helmholtz-Gemeinschaft die besten und originellsten Doktorarbeiten in den sechs Forschungsbereichen prämiert. Dr. Flávio Baleeiro erhielt den Preis für ein von ihm entwickeltes neuartiges biotechnologisches Verfahren zur Weiternutzung von CO2 und CO. |

|
Wirtschaft trifft Wissenschaft beim ersten UFZ-Innovationsforum „Wege zur Nachhaltigkeit“ Am 3. Juli 2023 tauschten sich 75 Expert:innen im Leipziger KUBUS zu nachhaltigen Herstellungsverfahren sowie Energie-, Wärme- und Abwasserkonzepten aus. |

|
Blau-grüne Infrastrukturen – ein Ansatz zwischen Wunsch, Notwendigkeit und Befindlichkeiten Am 28.06.2023 fand wieder ein Wirtschaftsgespräch vom Clusterteam „Natürliche Ressourcen“ im Netzwerk Energie und Umwelt e. V. statt. Im Mittelpunkt standen dabei blau-grüne Infrastrukturen, die dabei helfen, Städte resilienter gegenüber Klimaveränderungen zu gestalten. |

|
UFZ-Wissenschaftler gründet Unternehmen mit Marketingexpert*innen Friedrich Bohn, leidenschaftlicher Wissenschaftler am Helmholtz-Zentrum für Umweltforschung GmbH – UFZ, hat gemeinsam mit Marketingexpert*innen das Unternehmen BAM! Bock auf Morgen gegründet. |

|
UFZ-Lösungsansätze zur PFAS-Problematik in der Umwelt PFAS werden von der Industrie bei der Herstellung vieler Produkte verwendet. Doch sie reichern sich in Körper und Umwelt an. Das UFZ entwickelt deshalb Ansätze zum Umwelt-Monitoring, der toxikologischen Bewertung und zur Entfernung dieser toxischen PFAS aus Umwelt und Abfallströmen. |

|
UFZ erhält sein erstes europäisches Einheitspatent Das „Verfahren zur Herstellung von Carbonsäuren unter unsterilen Bedingungen“ wurde als erstes Einheitspatent am UFZ vom Europäischen Patentamt erteilt. |

|
Chemikalien für die Bioökonomie aus agroindustriellen Reststoffen CapUp-Projekt gestartet – Ein Forschungsteam von UFZ und DBFZ überführt zusammen mit Industriepartnern den Herstellungsprozess von Capron- und Caprylsäure aus regionaler Biomasse in den Pilotmaßstab |

|
Neue strategische Partnerschaft geschlossen Das UFZ und das Start-up Membran Tech GmbH vereinbaren eine Partnerschaft zur Entwicklung eines neuartigen Tensiometers zur großflächigen Messung des Wasserpotentials. |

|
Marine Metagenom-Daten für Forschende leicht zugänglich gemacht Mit der leistungsstarken, öffentlich zugänglichen MarineMetagenomeDB marine Metagenomproben mit kuratierten Metadaten finden und Metastudien über marine Mikrobiome durchführen. |

|
UFZ-Preise 2022 für Technologietransfer, Wissenstransfer und Nachwuchspreis für angewandte Forschung überreicht Das UFZ zeichnet jährlich herausragende Leistungen seiner Mitarbeitenden aus, Wege zu finden, eine gesunde Umwelt mit der gesellschaftlichen Entwicklung in Einklang zu bringen |
2022

|
Wissenschaftler des UFZ ist Preisträger der Energie und Umwelt Stiftung Leipzig Dr.-Ing. Matthias Jordan erhält den Förderpreis in der Kategorie Energie und Umwelt für seine Simulationsmethode zur Optimierung von Wärmekonzepten |

|
Expertentreffen am UFZ – Auftaktredner ist der Sächsische Staatsminister Wolfram Günther Unter dem Titel „CO₂-NEUtrale Stadt Leipzig – Wie geht's?“ lädt die ENERGIEMETROPOLE Leipzig am 21. November 2022 zu einem vielfältigen Programm in den Leipziger KUBUS ein. |

|
Emil-Ramann-Medaille 2022 an UFZ-Bodenwissenschaftler verliehen Auf der Jahrestagung 2022 der Deutschen Bodenkundlichen Gesellschaft (DBG) wurde Prof. Dr. Hans-Jörg Vogel mit dieser renommierten Auszeichnung gewürdigt. |

|
„Klimawandel - was können, was müssen wir tun?“: Clusterteam Natürliche Ressourcen diskutiert mit Employees For Future Das Clusterteam Natürliche Ressourcen im Netzwerk Energie & Umwelt e.V. veranstaltete im September 2022 sein reguläres Wirtschaftsgespräch zu diesem brisanten Thema. |

|
UFZ-Forschung auf der Transfermesse Sachsen-Anhalt Das Transfer- und Gründerzentrum der Otto-von-Guericke-Universität Magdeburg lud Universitäten, Hochschulen und Forschungseinrichtungen des Landes Sachsen-Anhalt ein, Ergebnisse aus deren Spitzenforschungen zu präsentieren. |

|
Gründachforschung – UFZ-Wissen zur Anpassung der Städte an den Klimawandel Seit April 2020 trägt das UFZ-Forschungsgründach zur Beantwortung aktueller Fragen zur optimierten Wirkung von Gründächern im urbanen Raum bei |

|
UFZ-Ausgründung gewinnt Innovationspreise RWInnoTec erhält für seine Radiowellen-Technologie zur Straßenreparatur IQ Innovationspreise. |

|
Cell4Chem: EU-Projekt zu Grünen Chemikalien In dem Projekt werden Strategien entwickelt, die das Potenzial mikrobieller Gemeinschaften erschließen. Dabei werden Konversionsprozesse erforscht. Das Ziel: Die Gewinnung hochwertiger Chemikalien aus nachhaltigen Rohstoffen. |

|
Arne Richter Award 2022 für mehrfach ausgezeichneten Nachwuchswissenschaftler Dr. Jakob Zscheischler, Gruppenleiter im Department Hydrosystemmodellierung am UFZ, wurde im Mai 2022 der Preis der Europäischen Geowissenschaftlichen Union (EGU) verliehen |

|
RWInnoTec nimmt erste Hürde bei Auszeichnung UFZ-Ausgründung ist für den IQ Innovationspreis Mitteldeutschland und den Sächsischen Gründerpreis nominiert. |

|
Nachwuchswissenschaftler erhält fünf Awards UFZ-Postdoktorand Dr. David Leuthold gewinnt für seine neue Methode zur Analyse von Neurotoxität Preise auf der Jahrestagung der Society of Toxicology (SOT) in San Diego, USA |

|
Neue Biomarker ebnen Weg für Spin-off Forschende haben neue Biomarker zur Detektion und Quantifizierung von Krebsarten und Ansatzpunkte für neue Krebsimmuntherapien entdeckt. Eine neue DKFZ/UFZ-Gründung nutzt dieses Know-how jetzt als Geschäftsidee. |

|
Das UFZ präsentierte auf der agra Leipzig Lösungen für Land- und Forstwirtschaft Die Landwirtschaftsausstellung in Mitteldeutschland brachte Forschende, Forst- und Landwirt*innen sowie Politiker*innen zusammen, um sich über aktuelle Forderungen und Möglichkeiten in der land- und forstwirtschaftlichen Produktion auszutauschen. |

|
Wasserstoff: Schlüsselelement der Energiewende Klimafreundlich hergestellter Wasserstoff ermöglicht es, die CO2-Emissionen in Industrie und Verkehr deutlich zu verringern. Dem UFZ wurde dazu jetzt ein europäisches Patent erteilt. |

|
UFZ im Expertengespräch – Jan Bumberger erklärt UFZ-Schwerpunkte zur Digitalisierung in den Umweltwissenschaften GTAI sprach mit Jan Bumberger, dem wissenschaftlichen Leiter des Bereichs Forschungsdatenmanagement am UFZ über die Herausforderungen bei der Entwicklung von Lösungen für den Klimawandel. |

|
Schutz vor Radon in Innenräumen – Ergebnisse aus Lüftungsexperimenten im Rahmen eines ZIM-Projektes des UFZ Das deutsche Strahlenschutzgesetz schreibt einen Referenzwert für Radonkonzentration in Innenräumen vor. In vielen Regionen Deutschlands übersteigen die Radonaktivitätskonzentrationen in der Bodenluft den Wert, sodass dort Maßnahmen zum Schutz der Bevölkerung getroffen werden müssen. |

|
transfun – gemeinsam Lösungen finden Das neue Förderprogramm transfun am UFZ stärkt die Zusammenarbeit mit nationalen und internationalen Unternehmen zur Entwicklung neuer Produkte. Gemeinsam mit Ihnen wollen wir an einer nachhaltigen Zukunft arbeiten und wertvolle Ressourcen schonen. Nutzen Sie die Chance, mit uns gemeinsam Ihre Idee zu entwickeln! |

|
Das UFZ unterstützt aktiv „Leipziger BlauGrün - Blau-grüne Quartiersentwicklung in Leipzig" Das UFZ entwickelt in Zusammenarbeit mit der Stadt Leipzig und weiteren Partnern ein Konzept für klimaangepasstes Wasser- und Energiemanagement am Beispiel des Quartiers Leipzig 416. |

|
UFZ-Preise 2021 für Technologietransfer, Wissenstransfer und Nachwuchspreis für angewandte Forschung überreicht Jährlich ehrt das UFZ herausragende Leistungen von UFZ-Mitarbeiter*innen und deren besonderes Engagement für das UFZ. |

|
Turf Coach UG Neue Ausgründung am UFZ bietet Lösungen für ein smartes und nachhaltiges Rasenmanagement. |
2021

|
Patente für UFZ-Technologie Carbo-Iron® erteilt Das UFZ erreicht zusammen mit seinem Partner Intrapore GmbH einen neuen Meilenstein bei der Vermarktung des aktivkohlebasierten In-situ-Ansatzes Carbo-Iron® zur Grundwasserreinigung. |

|
Schnüffeln für die Wissenschaft Artenspürhunde liefern wichtige Daten für Forschung und Naturschutz |

|
Vorhersage der ungebundenen Fraktion im Blut UFZ-Wissenschaftler*innen evaluierten die gängigsten Algorithmen zur Vorhersage von ungebundenen Anteilen einer medizinischen Substanz im menschlichen Körper. |

|
UFZ-Forscher*innen gründen die RWInnoTec GmbH Ein interdisziplinäres Team aus Physikern, Chemikern, Ingenieuren und Betriebswirtschaftlern des UFZ und der Hochschule für Wirtschaft, Technik und Kultur (HTWK) Leipzig haben Ende März 2021 die RWInnoTEC GmbH zur Entwicklung und Anwendung von Radiowellen gegründet. |

|
Hochwasser(eigen)vorsorge in Sachsen Das Clusterteam Natürliche Ressourcen im Netzwerk Energie und Umwelt e.V. veranstaltete im Mai sein erstes virtuelles Wirtschaftsgespräch in 2021. |

|
Neue EXIST-Gründerinitiative am UFZ gestartet Gründungsinitiative SMART GREEN MONITORING erhält EXIST-Gründerstipendium für die Entwicklung eines smarten und nachhaltigen Rasenmanagements bei Sportvereinen |
|
Auf dem Weg zur Entwicklung nachhaltiger Bioprozesse Zwei Studien zeigen aktuelle Entwicklungen in der Bioreaktortechnologie für die kontinuierliche Produktion von Chemikalien mit Biofilmen. |

|
Unternehmerisches Denken und Handeln wird zum Selbstverständnis Die Hochschule Merseburg und das UFZ wollen in dem Projekt „Gründercampus HoMe“ gemeinsam ihren Gründerservice als Teil regionaler und überregionaler Netzwerke etablieren. Aus einer guten Idee soll sich eine erfolgreiche Gründung mit langfristiger Perspektive aufbauen. |

|
Biomarker zur Detektion und Quantifizierung von Krebsarten entdeckt Trotz großer Fortschritte in der Diagnostik ist es bei einigen Krebsarten immer noch schwer, diese zu detektieren und das Stadium zu bestimmen. Hierfür wurden jetzt zwei neue Biomarker von Wissenschaftler*innen des Deutschen Krebsforschungszentrums und des UFZ beschrieben. |

|
Elektro-Biosanierung von Grundwasser Eine vom UFZ mitentwickelte mikrobielle elektrochemische Technologie (MET) zur Behandlung von nitrat- und arsenitbelastetem Grundwasser. |

|
BiodivERsA-Preis an TALE-Projekt verliehen Das von dem UFZ-Wissenschaftler Martin Volk koordinierte TALE-Projekt gewinnt die 4. Auflage des BiodivERsA-Preises für Exzellenz und Impact. Der Preis würdigt die exzellente, zukunftsweisende Forschung, die in TALE geleistet wird. |
|
|
Zytometrische Mikrobiomanalyse In der Durchflusszytometrie sind Beads zur Kalibrierung wertvoll, aber oft für standardisierte Laborabläufe oder Experimente nicht ausreichend. Die zytometrische Mock-Community des UFZ löst diese Probleme. Lassen Sie uns gemeinsam einen Kit entwickeln! |

|
Wasserstoff aus Cyanobakterien Johanna Wiedener hat im UFZ-Department Solare Materialien ihre Masterarbeit angefertigt. Dafür wurde sie mit einem Preis der Deutschen Botanischen Gesellschaft ausgezeichnet. |

|
14. Treffen des Sächsischen Transfer-Netzwerkes Das UFZ war Gastgeber des virtuellen Treffens von futureSax am 3. Februar. Ein Impulsvortrag informiert über die Fortschritte im Technologietransfer am UFZ. |

|
Ausbau der Kooperation zwischen HTWK und UFZ Der Kooperationsvertrag des UFZ mit dem Forschungs- und Transferzentrum (FTZ) an der HTWK wird die wissenschaftliche Expertise am Wissenschaftsstandort Leipzig weiter stärken. |

|
Prof. Dr. Daniela Thrän Ko-Vorsitzende im Bioökonomierat Der Bioökonomierat ist ein Beratungsgremium der Bundesregierung mit der Aufgabe, wichtige Anregungen zur Nationalen Forschungsstrategie Bioökonomie 2030 und zur Nationalen Politikstrategie Bioökonomie zu liefern. |

|
Prof. Dr. Katja Bühler in den Nationalen Wasserstoffrat berufen Aufgabe des Expertengremiums ist es, die Bundesregierung durch Handlungsempfehlungen zu beraten, um die im Jahr 2020 beschlossene Nationale Wasserstoffstrategie umzusetzen und weiterzuentwickeln. |

|
Vorhersage mitochondrialer Dysfunktion Forschende am UFZ haben ein biophysikalisches Modell entwickelt, um die pH-abhängige Entkopplungstoxizität organischer Säuren anhand deren chemischer Struktur vorherzusagen. |

|
Schnelle Identifikation neurotoxischer Effekte Für eine schnelle Bewertung von Umweltproben optimierten Forschende des UFZ die Messung eines Verhaltensendpunktes in Zebrafischembryonen. |
2020
 Um Produkte erfolgreich in den Markt zu bringen, muss der Herstellungsprozess heutzutage nicht nur wirtschaftlich, sondern auch sozioökonomisch und ökologisch vertretbar sein. Mit Wissenschaftler*innen um Norbert Kohlheb (Department Umwelt- und Biotechnologisches Zentrum) und Jens Krömer (Department Solare Materialien) verfügt das UFZ über Expertise, um im Rahmen einer frühzeitigen Nachhaltigkeitsbetrachtung Prozessparameter und -kosten für die Skalierung biotechnologischer Verfahren zu analysieren. Beispiele für nachhaltige Verfahren betreffen die Synthese „grüner Chemikalien“ wie Citronensäure aus Altfetten (1) oder para-Hydroxybenzoesäure als Modellprozess für biobasierte Aromaten (2) aber auch Verfahren zur Behandlung von Abwasser mit Algen und Bakterien (3).
Um Produkte erfolgreich in den Markt zu bringen, muss der Herstellungsprozess heutzutage nicht nur wirtschaftlich, sondern auch sozioökonomisch und ökologisch vertretbar sein. Mit Wissenschaftler*innen um Norbert Kohlheb (Department Umwelt- und Biotechnologisches Zentrum) und Jens Krömer (Department Solare Materialien) verfügt das UFZ über Expertise, um im Rahmen einer frühzeitigen Nachhaltigkeitsbetrachtung Prozessparameter und -kosten für die Skalierung biotechnologischer Verfahren zu analysieren. Beispiele für nachhaltige Verfahren betreffen die Synthese „grüner Chemikalien“ wie Citronensäure aus Altfetten (1) oder para-Hydroxybenzoesäure als Modellprozess für biobasierte Aromaten (2) aber auch Verfahren zur Behandlung von Abwasser mit Algen und Bakterien (3).
Publikationen:
(1) Early‐stage sustainability assessment of biotechnological processes: A case study of citric acid production, doi.org/10.1002/elsc.201800198
(2) Economic Process Evaluation and Environmental Life-Cycle Assessment of Bio-Aromatics Production, doi: 10.3389/fbioe.2020.00403
(3) Assessing the life-cycle sustainability of algae and bacteria-based wastewater treatment systems: High-rate algae pond and sequencing batch reactor, doi.org/10.1016/j.jenvman.2020.110459
Weitere Informationen:
Dr. Norbert Kohlheb (
norbert.kohlheb@ufz.de
), Department Umwelt- und Biotechnologisches Zentrum
Dr. Jens Krömer (
jens.kroemer@ufz.de
), Department Solare Materialien
November 2020
 im VisLab am UFZ, Foto: UFZ
im VisLab am UFZ, Foto: UFZ
Heutzutage stehen immer mehr Daten aus der Fernerkundung und aus Simulationen zur Analyse komplexer Umweltprozesse zur Verfügung. Die Analyse dieser Prozesse kann durch eine geeignete Visualisierung der Daten erleichtert werden. Mit dem TESSIN VisLab verfügt das UFZ über eine einzigartige Forschungsinfrastruktur, die Hardware, u.a. einen 6 m x 3 m großen Hauptbildschirm, sowie Visualisierungs- und Virtual-Reality-Software zur Darstellung von Forschungsdaten aus terrestrischen Systemen kombiniert. Typische Anwendungen reichen von der Wasserversorgung in urbanen Systemen, über die Grundwasseranalyse in Hydrosystemen bis hin zur Erforschung von geothermischen Energiesystemen oder Klima- und Ökosystemen. Die anschauliche Visualisierung regt nicht nur den wissenschaftlichen Austausch an, sondern ermöglicht auch den Wissenstransfer zu Entscheidungsträger*innen und der breiten Öffentlichkeit.
Gemeinsam mit chinesischen Forschenden entwickelten die UFZ-Experten Dr. Karsten Rink und Lars Bilke vom UFZ-Department Umweltinformatik eine Software-Plattform zur 3D-Visualisierung Umweltdaten, etwa zur Darstellung von Gelände, Wetter, Flussnetz, Wasserstand, Landnutzungsänderungen und Zusammenhänge zwischen diesen Datensätzen. Zu diesem Zweck werden mehrere Softwarewerkzeuge genutzt: OpenGeoSys Data Explorer und ParaView für die Datenintegration und -verarbeitung, sowie Unity, eine aus 3D-Spielen bekannte Engine, und MiddleVR, ein Virtual Reality Werkzeug, um dem Betrachtenden die Interaktion mit der 3D-Welt zu ermöglichen. Der OpenGeoSys Data Explorer wird als Datenintegrationswerkzeug der OpenGeoSys Simulationssoftware direkt am UFZ entwickelt. Zusammenfassend stellt das Forschungsteam ein frei nutzbares, standardisiertes Software-Framework zur Verfügung und zeigt die Machbarkeit für das chinesische Poyang-Seebecken auf. Darüber hinaus kann das Software-Framework als Plattform genutzt werden und problemlos auf andere Regionen der Welt, die mit Umweltproblemen konfrontiert sind, angewendet werden.
Publikation:
K. Rink, E. Nixdorf, C. Zhou, M. Hillmann, L. Bilke. A Virtual Geographic Environment for Multi-Compartment Water and Solute Dynamics in Large Catchments. J. Hydrol 582, art. 124507 (2020)
https://doi.org/10.1016/j.jhydrol.2019.124507
Kontakt und weitere Informationen:
Dr. Karsten Rink,
karsten.rink@ufz.de
Lars Bilke,
lars.bilke@ufz.de
TESSIN VISLab
OpenGeoSys
Video auf YouTube
November 2020
 In Kooperation mit dem Leipzig Science Network lädt futureSAX am 03.11.2020 dazu ein, die Wissenschaftsregion Leipzig zu entdecken.
In Kooperation mit dem Leipzig Science Network lädt futureSAX am 03.11.2020 dazu ein, die Wissenschaftsregion Leipzig zu entdecken.
Auch das UFZ ist bei diesem ersten Sächsischen Transferforum dabei, um den Austausch zu Best-Practice-Beispielen des sächsischen Wissens- und Technologietransfers zu unterstützen und die Wissenschaftsregion Leipzig kennenzulernen.
Das UFZ bringt dafür seine Erfahrungen aus dem vom BMBF geförderten Drittmittelprojekt „Sektorale Verwertung – Professionalisierung des Technologietransfers am UFZ“ (FKZ: 01IO1424) mit, das 2018 erfolgreich endete.
Kernergebnisse der Förderung waren die Etablierung effizienter Prozesse, die Entwicklung einer Transferprojekt-Pipeline mit gezielten Maßnahmen zur Weiterentwicklung priorisierter Transferprojekte, die Stärkung des Technologiemarketings sowie die Professionalisierung des Schutzrechtsmanagements inklusive Auslizenzierung. Zum Abschluss des Projektes wurden noch einmal die entwickelten Werkzeuge und Prozesse mit der Atrineo AG, einer externen Verwertungsagentur, diskutiert und überprüft.
Neben spannenden Impulsvorträgen und Diskussionsrunden finden vier Workshops statt, die sich an eine Transfer-Community aus Wissenschaft und Wirtschaft, interessierte Wissenschaftlerinnen und Wissenschaftler sowie Multiplikatoren richtet.
Das UFZ freut sich auf die spannende Veranstaltung und auf Sie!
Hier können Sie sich anmelden.
Wollen Sie mehr zu unseren entwickelten Technologien und Verfahren wissen? Dann kontaktieren Sie uns:
Joachim Nöller, Abt. WTT ( joachim.noeller@ufz.de )
Oktober 2020
 © EPA
Bei der Patentierung innovativer Technologien tappen viele Forscherinnen und Forscher unwissentlich in vermeidbare Fallen und gefährden damit einen Schutz ihrer wertvollen Ideen.
© EPA
Bei der Patentierung innovativer Technologien tappen viele Forscherinnen und Forscher unwissentlich in vermeidbare Fallen und gefährden damit einen Schutz ihrer wertvollen Ideen.
Am 25. September 2020 organisierte die Abteilung WTT deshalb ein Seminar mit dem Titel „How to write a patent application“ als Anleitung zum Schreiben und Anmelden von Patenten. Dozent war der Patentanwalt Dr. Jens Glienke von der Patent- und Rechtsanwaltskanzlei Gulde & Partner aus Berlin. Glienke ist studierter Biologe und war zunächst in der Onkologieforschung und -entwicklung tätig, bevor er als Patentreferent eines Pharmaunternehmens in den gewerblichen Rechtsschutz wechselte. Am UFZ stellte Glienke seine Expertise in den Bereichen der Patentanalyse und Patentanmeldeverfahren zur Verfügung und sprach über Schutzrechte, Patentierungsmöglichkeiten und -bedingungen und bot eine praktische Anleitung zum Verfassen von Patenten. Unter Berücksichtigung möglicher Stolperfallen ging Glienke vor allem auf die Formulierung, Struktur und inhaltlichen Anforderungen einer Patentanmeldung ein.
Dieses Seminar wurde im Rahmen des Beratungsangebots der WTT-Abteilung für Unternehmerinnen und Unternehmer angeboten.
Kontakt: Abt. WTT, Joachim Nöller ( joachim.noeller@ufz.de )
Oktober 2020
 © i.Stock.com/viafilms / Logo: BMI
Die deutsche Wasserwirtschaft steht vor neuen Herausforderungen: Klimawandel, demografische Entwicklungen, Landnutzungsänderungen, technologische Neuerungen und verändertes Konsumverhalten bringen umfassende Veränderungen mit sich. Zudem führen neue politische Rahmenbedingungen, wie beispielsweise der EU-Haushalt oder Änderungen in der gemeinsamen Agrarpolitik zu anderen Schwerpunkten und Herausforderungen.
© i.Stock.com/viafilms / Logo: BMI
Die deutsche Wasserwirtschaft steht vor neuen Herausforderungen: Klimawandel, demografische Entwicklungen, Landnutzungsänderungen, technologische Neuerungen und verändertes Konsumverhalten bringen umfassende Veränderungen mit sich. Zudem führen neue politische Rahmenbedingungen, wie beispielsweise der EU-Haushalt oder Änderungen in der gemeinsamen Agrarpolitik zu anderen Schwerpunkten und Herausforderungen.
Grundlage für die Transformation der Wasserwirtschaft – der Nationale Wasserdialog
Als Grundlage für die Transformation der Wasserwirtschaft haben das Bundesumweltministerium und das Umweltbundesamt gemeinsam den Nationalen Wasserdialog durchgeführt, der vom UFZ fachlich intensiv bearbeitet und begleitet wurde. In diesem zweijährigen Dialogprozess haben Fachleute aus Wissenschaft, Wirtschaft, Praxis, Verwaltung und Interessenvertretungen die wesentlichen zukünftigen Herausforderungen, Leitlinien sowie Ziele identifiziert. Es wurden Handlungsoptionen und Aktionsfelder für die künftige Entwicklung der deutschen Wasserwirtschaft sowie den Umgang mit Wasser und Gewässern erarbeitet.
Mit dem 2. Nationalen Wasserforum am 8. Oktober 2020 wurde dieser Dialogprozess abgeschlossen und der Abschlussbericht zum Nationalen Wasserdialog an die Bundesumweltministerin und den Präsidenten des Umweltbundesamts übergeben. Zeitgleich wurden die Kernbotschaften in einer Broschüre zusammengefasst und veröffentlicht. Dazu zählen u.a.
• Wertschätzung von Wasser in Politik und Gesellschaft sowie die intersektorale Vernetzung stärken,
• Gewässer- und Naturschutz besser verbinden,
• Land- und Wasserwirtschaft entwickeln gemeinsam Standards für eine gewässersensible Landnutzung.
So geht es weiter
Das BMU wird die Bausteine aus dem Nationalen Wasserdialog als wesentlichen inhaltlichen Beitrag für die Erarbeitung einer Nationalen Wasserstrategie mit dem Zeithorizont 2050 nutzen. Die Veröffentlichung des Entwurfs der BMU – Wasserstrategie ist für Juni 2021 vorgesehen.
Kontakt: Dietrich Borchardt ( dietrich.borchardt@ufz.de )
Oktober 2020
 Ob Strom aus Abwasser gewinnen oder Zitronensäure aus altem Frittenöl herstellen – beim virtuellen 3rd ECP Summer Summit suchte die Abteilung Wissens- & Technologietransfer Partner zur Umsetzung von UFZ-Innovationen.
Ob Strom aus Abwasser gewinnen oder Zitronensäure aus altem Frittenöl herstellen – beim virtuellen 3rd ECP Summer Summit suchte die Abteilung Wissens- & Technologietransfer Partner zur Umsetzung von UFZ-Innovationen.
Die European Chemistry Partnering in Frankfurt am Main ist eine wichtige Kontaktbörse für die Chemiebranche in Deutschland und darüber hinaus. Wegen Corona trafen sich diesmal im Rahmen eines virtuellen 3rd ECP Summer Summits vom 17.-18. September 2020 über 430 Teilnehmende aus 46 Ländern, um sich in Workshops, Ausstellungen und Pitches über innovative Ideen und Technologien zu den 17 Zielen für eine nachhaltige Entwicklung von den Vereinten Nationen (UN) auszutauschen und Partnerschaften anzubahnen. Begleitend konnten deshalb 20-minütige Eins-zu-eins-Gespräche im Stil eines „Speeddatings“ vereinbart werden, um Partnerschaften für eine Umsetzung zu schließen. Insgesamt fanden über 1.000 dieser Meetings virtuell statt.
Die Abteilung Wissens- & Technologietransfer nutzte diese Veranstaltung, um anwendungsnahe Technologieansätze aus dem Themenbereich Umwelt- und Biotechnologie potenziellen Partnern aus der Praxis vorzustellen. Im Mittelpunkt standen diesmal Technologien, mit denen aus regionalen Abfallströmen wertvolle Stoffe wie Zitronensäure, Isocitrat, Biokraftstoffe oder Capron- und Caprylsäureester zu synthetisiert werden können.
Ein bewährtes Partnering-Format, das auch in Zukunft umfangreich genutzt werden wird!
Für Rückfragen und Hinweise:
Abt. WTT, Joachim Nöller (
joachim.noeller@ufz.de
)
September 2020
 Von links: Heiko Bär, Dr. Joachim Nöller, Dr. Sabine König, Prof. Dr. Getu Abraham und Anja Feichtinger (nicht im Bild: Dr. Falk-Thoralf Günther, SPD-Fraktionsgeschäftsführer).
Von links: Heiko Bär, Dr. Joachim Nöller, Dr. Sabine König, Prof. Dr. Getu Abraham und Anja Feichtinger (nicht im Bild: Dr. Falk-Thoralf Günther, SPD-Fraktionsgeschäftsführer).
Foto: Dr. Falk-Thoralf Günther
Im Zuge einer kleinen Sommertour machte sich die SPD-Fraktion Leipzig auf Initiative ihres wirtschaftspolitischen Sprechers Heiko Bär ein Bild von den verschiedenen Gründerzentren, die in Leipzig im Umfeld wissenschaftlicher Einrichtungen entstanden sind.
Am 25.09.2020 stand das Helmholtz-Zentrum für Umweltforschung - UFZ auf dem Besuchsprogramm, wo die Stadtratsfraktionsmitglieder*innen von der administrativen Geschäftsführerin Frau Dr. Sabine König und Herrn Dr. Joachim Nöller, Leiter der Abteilung Wissens- und Technologietransfer, begrüßt wurden.
In dem spannenden Austausch ging es nicht nur um Unternehmensgründungen, Politikberatung oder Klimawandel, auch über die Verbesserung der Rahmenbedingungen für den Technologietransfer in Leipzig wurde gesprochen.
Kontakt: Abt. WTT, Joachim Nöller ( joachim.noeller@ufz.de )
September 2020
 Wissensaustausch und Kooperationsbeziehungen zwischen Wissenschaft und Partnern aus Wirtschaft, Politik, Kultur oder Zivilgesellschaft gewinnen für Hochschulen an Bedeutung. Sie sind immer mehr gefordert, darzustellen, wie erfolgreich ihre Transfer-Aktivitäten zur gesellschaftlichen und wirtschaftlichen Entwicklung beitragen. Um die Erfolgsmessung den Hochschulen zu erleichtern, entwickeln Stifterverband, Helmholtz-Gemeinschaft und Stiftung Mercator zusammen mit ausgewählten Forschungseinrichtungen und Hochschulen das Transferbarometer. Beteiligte Hochschulen sind RWTH Aachen, HTW Dresden, Universität Düsseldorf, Universität Kassel und Hochschule München.
Wissensaustausch und Kooperationsbeziehungen zwischen Wissenschaft und Partnern aus Wirtschaft, Politik, Kultur oder Zivilgesellschaft gewinnen für Hochschulen an Bedeutung. Sie sind immer mehr gefordert, darzustellen, wie erfolgreich ihre Transfer-Aktivitäten zur gesellschaftlichen und wirtschaftlichen Entwicklung beitragen. Um die Erfolgsmessung den Hochschulen zu erleichtern, entwickeln Stifterverband, Helmholtz-Gemeinschaft und Stiftung Mercator zusammen mit ausgewählten Forschungseinrichtungen und Hochschulen das Transferbarometer. Beteiligte Hochschulen sind RWTH Aachen, HTW Dresden, Universität Düsseldorf, Universität Kassel und Hochschule München.
Aus der Helmholtz-Gemeinschaft Deutscher Forschungszentren werden folgende Zentren teilnehmen: Deutsches Zentrum für Neurodegenerative Erkrankungen (DZNE) in Bonn, Deutsches Elektronen-Synchrotron DESY in Hamburg, das Forschungszentrum Jülich sowie das Karlsruher Institut für Technologie (KIT), das Helmholtz-Zentrum für Umweltforschung – UFZ in Leipzig und das CISPA-Helmholtz-Zentrum für Informationssicherheit, Saarbrücken.
„Die Gesamtauswahl bildet die fachliche Breite der vielfältigen Transfer-Aktivitäten ab“, resümiert Andrea Frank, Leiterin des Aktionsfeldes Wissenschaft im Stifterverband. „Vielfältigkeit war uns auch bei der Auswahl der teilnehmenden Hochschulen wichtig. Denn das Transferbarometer soll quantitative und qualitative Indikatoren für unterschiedliche Transferprofile entwickeln – gemeinsam mit Forschungseinrichtungen und Hochschulen, von der Community für die Community.“
Da es bei diesem Thema keine pauschale Lösung für alle geben kann, entwickeln die Partner im Projekt einen Katalog mit Kennzahlen für unterschiedliche Transferprofile. Ziel ist es, dass die Ergebnisse auch für andere Hochschulen und Forschungseinrichtungen mit vergleichbaren Transferprofilen anwendbar sind.
Ausführliche Informationen zum Transferbarometer finden Sie hier.
Kontakte:
Peggy Groß
Pressereferentin
T 030 322982-530
presse@stifterverband.de
http://www.stifterverband.org
Andrea Frank
Leiterin Aktionsfeld Wissenschaft
T 030 322982-502
andrea.frank@stifterverband.de
Die gesamte Pressemitteilung ist hier abrufbar.
September 2020
 Correlia user interface
Correlia user interface
Foto: Matthias Schmidt
Effizientere Datenauswertung von Mikroskopieaufnahmen
Die kostenlose und frei zugängliche Software Correlia soll Forscherinnen und Forschern bei der Datenauswertung im Bereich der korrelativen Mikroskopie unterstützen. Sie wurde gemeinsam von einem Masterstudenten der Hochschule für Technik, Wirtschaft und Kultur (HTWK) Leipzig sowie von UFZ- und HTWK-Forschenden am ProVIS-Zentrum des UFZ entwickelt.
Verschiedene mikroskopische Modalitäten ein und derselben Probe aufeinander registrieren und die enthaltenen Informationen verknüpfen?
Mit der frei zugänglichen Software Correlia kein Problem. So können beispielsweise lichtoptische Bilder der Anatomie der Proben im Lebendzustand, rasterelektronenmikroskopische Aufnahmen der Feinstruktur nach Fixierung und Trocknung sowie massenspektrometrische Bilder der chemischen Zusammensetzung aus dem bildgebenden Sekundärionen-Massenspektrometer kombiniert werden.
Diese Überlagerung erfordert, dass variierende Bildausschnitte aufeinander ausgerichtet wer-den müssen. Zudem müssen innerhalb der jeweiligen "Region of Interest" die modalitätsbe-dingten nichtlinearen Abbildungsfehler und die präparierungsbedingten Verzerrungen der Probe kompensiert und so Bilder verschiedener Modalitäten möglichst exakt in Deckung gebracht werden.
„Der zentrale Vorteil der Correlia-Software ist, dass sie Forschenden erlaubt, Mikrographien verschiedener Mikroskophersteller und unterschiedlicher Modalitäten in einem Projekt zu kor-relieren und zu verwalten. Wir haben dadurch ein Hilfsmittel für korrelative Mikroskopie-Workflows, wie sie am ProVIS etabliert wurden, geschaffen, von dem wir hoffen, dass es auch an anderen Mikroskopieplattformen weltweit Verwendung finden wird“, so Matthias Schmidt von ProVIS.
Die Dokumentation der Software publizierten die Forschenden in der Oktoberausgabe des Fachblatts "Journal of Microscopy". Eine Abbildung daraus ziert deren Cover.
Publikation:
Florens Rohde, Ulf-Dietrich Braumann, Matthias Schmidt: Correlia: an ImageJ plug‐in to co‐register and visualise multimodal correlative micrographs; Journal of Microscopy. https://doi.org/10.1111/jmi.12928
Kontakt: Matthias Schmidt, ProVIS ( matthias.schmidt@ufz.de )
September 2020
 Die hohe Zahl von Richtlinien und Strategien zur Bioökonomie zeigt das Interesse an der Bioökonomie in vielen Ländern. Die Entwicklung der Bioökonomie birgt Chancen, aber auch Risiken für die Nachhaltigkeit. Daher sollte die zukünftige Entwicklung einer nachhaltigen Bioökonomie auf kohärenten politischen Rahmenbedingungen basieren.
Die hohe Zahl von Richtlinien und Strategien zur Bioökonomie zeigt das Interesse an der Bioökonomie in vielen Ländern. Die Entwicklung der Bioökonomie birgt Chancen, aber auch Risiken für die Nachhaltigkeit. Daher sollte die zukünftige Entwicklung einer nachhaltigen Bioökonomie auf kohärenten politischen Rahmenbedingungen basieren.
Die Studie von UFZ-Wissenschaftlern in Zusammenarbeit mit SQ Consult, TU Berlin und DBFZ zeigt einen deutlichen Bedarf auf, die Kohärenz zwischen den in den verschiedenen Bioökonomie-Rahmenwerken enthaltenen Nachhaltigkeitskriterien zu erhöhen. Ziel wäre es, dabei eine einheitlichere Terminologie der Nachhaltigkeitsanforderungen, Bioökonomie-Definitionen usw. zu erreichen. Überwachungsansätze sollten politische Ziele, Nachhaltigkeitsanforderungen und -risiken berücksichtigen und diese dynamisch anpassen.
Ziel dieser Studie war es, zu evaluieren, wie die derzeitigen politischen Rahmenbedingungen der EU für Bioökonomie, Nachhaltigkeitsaspekte berücksichtigen und ob nichtstaatliche Governance-Ansätze deren Verbesserung unterstützen könnten.
Dabei wurden in 56% der Grundsatzdokumente Nachhaltigkeitsanforderungen identifiziert. Der Einfluss politischer Rahmenbedingungen auf die Branche wurde als eher gering eingestuft. Spezifische Ziele und Vorgaben sind in 72% der analysierten Bioökonomie-Strategiepapiere enthalten, aber nur 50% sind quantifizierbar. Die Identifizierung der wichtigsten Nachhaltigkeitsrisiken ergab, dass in der Phase der Biomasseproduktion vor allem Umweltrisiken am relevantesten sind. Ein "Hot-Spot-Sektor" mit kumulierter Wahrnehmung von Nachhaltigkeitsrisiken oder einer Tendenz zu höheren Risikoniveaus wurde nicht identifiziert. Die wichtigsten Wahrnehmungen der Nachhaltigkeitsrisiken stimmten mit den Anforderungen in Grundsatzdokumenten überein, aber die Anforderungen wurden meist unverbindlich formuliert.
Weitere Ergebnisse finden Sie in der Studie:
Strengths and gaps of the EU frameworks for the sustainability assessment of bio-based products and bioenergy
Von: D. Moosmann, S. Majer, S. Ugarte, L. Ladu, S. Wurster, D. Thrän
In Energy, Sustainability and Society, May 2020, DOI: 10.1186/s13705-020-00251-8
Download hier
August 2020
 Carbo Iron aus kolloidaler Aktivkohle und Eisen zur Reinigung chemisch verunreinigtem Grundwasser, Foto: UFZ
Intrapore, exklusiver Lizenznehmer von Carbo-Iron®, setzte erfolgreich 500 kg des innovativen Kompositmaterials bei einem Schadensfall in Deutschland ein.
Carbo Iron aus kolloidaler Aktivkohle und Eisen zur Reinigung chemisch verunreinigtem Grundwasser, Foto: UFZ
Intrapore, exklusiver Lizenznehmer von Carbo-Iron®, setzte erfolgreich 500 kg des innovativen Kompositmaterials bei einem Schadensfall in Deutschland ein.
Glückwunsch! Für das UFZ und Intrapore war es ein harter Weg von der Entwicklung bis zur Erprobung des Kompositmaterials Carbo-Iron® in zahlreichen erfolgreichen Feldstudien.
Mit dem nun erreichten Meilenstein ist endgültig der Weg geebnet, um andere Großschadensfälle anzugehen. Allein in Deutschland – einer Industrienation mit höchsten Umweltstandards und -auflagen – gibt es über 300.000 Altlastenverdachtsfälle, von denen 15.000 bereits als Altlast eingestuft worden sind. Dafür werden dringend Sanierungsmethoden gebraucht.
Intrapore und das UFZ nehmen diese Herausforderung an und werden auch weiter gemeinsam an neuartigen Materialien arbeiten, um in Zukunft zum Beispiel per- und polyfluorierte Chemikalien (PFAS) umweltfreundlich abbauen zu können.
Für weitere Informationen kontaktieren Sie bitte:
Dr. Joachim Nöller (
joachim.noeller@ufz.de
), UFZ, Abteilung Wissens- und Technologietransfer
Dr. Julian Bosch (
info@intrapore.com
), Intrapore GmbH
August 2020
 Schadstoffabbau im Zeolith, Grafik: UFZ
Perfluoroctansäure (PFAS) gibt aufgrund ihrer Persistenz in der Umwelt und ihrer globalen Verbreitung als industrielles Tensid in chemischen Prozessen oder als Ausgangsstoff für Materialien Anlass zu Besorgnis. Effiziente Abbaustrategien sind bisher begrenzt. UFZ-Wissenschaftler*innen um Dr. Anett Georgi vom Department Technische Umweltchemie haben einen neuartigen Ansatz für den PFAS-Abbau mittels UV-A-Bestrahlung nach Adsorption an kolloidalen Fe-Zeolithen, genannt Trap-Ox©, entwickelt und nun erste Ergebnisse dazu veröffentlicht.
Schadstoffabbau im Zeolith, Grafik: UFZ
Perfluoroctansäure (PFAS) gibt aufgrund ihrer Persistenz in der Umwelt und ihrer globalen Verbreitung als industrielles Tensid in chemischen Prozessen oder als Ausgangsstoff für Materialien Anlass zu Besorgnis. Effiziente Abbaustrategien sind bisher begrenzt. UFZ-Wissenschaftler*innen um Dr. Anett Georgi vom Department Technische Umweltchemie haben einen neuartigen Ansatz für den PFAS-Abbau mittels UV-A-Bestrahlung nach Adsorption an kolloidalen Fe-Zeolithen, genannt Trap-Ox©, entwickelt und nun erste Ergebnisse dazu veröffentlicht.
Zeolithe eignen sich sehr gut als Träger für Oxidationskatalysatoren, da sie hochporös und selbst oxidationsbeständig sind (anders als z.B. Aktivkohle). Eisen kann durch Ionenaustausch eingebaut werden und kann als effizienter Katalysator z.B. zur Aktivierung von Wasserstoffperoxid über einen weiten pH-Bereich fungieren.
In der hier zitierten Arbeit veröffentlichten UFZ-Wissenschaftler*innen unter Beteiligung eines Kollegen von der IQS Barcelona erste Ergebnisse zur Verwendung dieses Materials in einem neuen Ansatz zum Abbau von PFOA. Der extrem persistente Schadstoff kann nach Adsorption in den Fe-Zeolith durch Bestrahlung mit UV-A-Licht und Nutzung von Luftsauerstoff als Oxidationsmittel zerstört werden. Das Material verhielt sich gegenüber dem homogenen System mit gelösten Fe(III)-Ionen in Bezug auf Leistung, Betriebs-pH- und UV-Bereich überlegen. Die veröffentlichten Ergebnisse bestätigten die Recyclingfähigkeit des Katalysators und die Toleranz gegenüber relevanten anorganischen Anionen. Der neue Ansatz erlaubt daher eine kommerzielle Verwertung für die PFAS-Entfernung aus kontaminierten Wässern durch Adsorption gekoppelt mit einer Vor-Ort-Regenerierung des Adsorbens.
Neben diesem neuartigen Ansatz entwickelt das UFZ einen ganzen Werkzeugkasten von Methoden zur Sanierung kontaminierter Grundwasserleiter. Dabei fokussiert sich das UFZ auf die Optimierung von Trap-Ox©-Fe-Zeolithen zum Abbau verschiedener Perfluoralkyl-Substanzen in Festbettreaktoren und Erzeugung von Sulfatradikalen aus Persulfat als Oxidationsmittel zur Regeneration der Fe-Zeolithe (EP3646946A1). Eine weitere Anwendung ist die in-situ-Sanierung im Fall von Grundwasserkontaminationen mit flüchtigen chlorierten Kohlenwasserstoffen unter Verwendung von Hydroxyl-Radikalen. Eine erste Feldstudie hat in diesem Jahr zusammen mit unserem Partner Intrapore GmbH an einem kontaminierten Standort in Deutschland begonnen.
Publikation:
“Degradation of perfluorooctanoic acid adsorbed on Fe-zeolites with molecular oxygen as oxidant under UV-A irradiation”, L. Qian, A. Georgi, R. Gonzalez-Olmos, F.-D. Kopinke in Applied Catalysis B: Environmental, December 2020, Link
Weitere Informationen: Dr. Anett Georgi, anett.georgi@ufz.de , Department Technische Umweltchemie
August 2020
 UFZ-Forscher im MOBICOS-Container, Foto: UFZ
Zwei neue Fallstudien belegen die Vielseitigkeit von MOBICOS - einer neuen modularen Forschungsinfrastruktur des UFZ zur Untersuchung hydro-ökologischer Prozesse über verschiedene Einzugsgebietsskalengradienten.
UFZ-Forscher im MOBICOS-Container, Foto: UFZ
Zwei neue Fallstudien belegen die Vielseitigkeit von MOBICOS - einer neuen modularen Forschungsinfrastruktur des UFZ zur Untersuchung hydro-ökologischer Prozesse über verschiedene Einzugsgebietsskalengradienten.
MOBICOS ist eine einzigartige Forschungsplattform des UFZ aus acht mobilen, containerbasierten Fließwasserlaboren, welche die Analyse von ökologischen Prozessen in Fließgewässern nahezu so natürlich wie unter Freilandbedingungen und so kontrollierbar wie im Labor ermöglicht. UFZ-Wissenschaftler*innen haben in ihrer Publikation die Vielseitigkeit der experimentellen Infrastruktur anhand von zwei sehr unterschiedlichen Fallstudien aufgezeigt.
Warum wurde MOBICOS entwickelt?
Ein zentrales Forschungsziel für Litoral-Ökosysteme ist die Identifizierung natürlicher und anthropogener Belastungen, die den Zustand und die Funktionen von Ökosystemen beeinflussen. Als Folge dieser Störungen sind viele Litoral-Ökosysteme komplexen Kombinationen von nicht-chemischen und chemischen Stressoren ausgesetzt. Zu diesen Stressoren gehören Temperatur-schwankungen, Strömungsänderungen, erhöhte Stofffrachten oder Xenobiotika, und all diese Faktoren können aquatische Ökosysteme auf verschiedenen zeitlichen, räumlichen und biologischen Skalen belasten. Faktorielle Experimente sind daher unerlässlich, um kausale Zusammenhänge insbesondere zwischen kombinierten Stressoren und ihren Auswirkungen in der Umwelt aufzudecken. Experimentelle Instrumente, die die Komplexität von Fließgewässern über verschiedene Ökosystemkompartimente, Ebenen der biologischen Organisation, natürliche oder anthropogene Umweltgradienten und die Reproduzierbarkeit berücksichtigen, sind jedoch selten.
MOBICOS im Überblick
Die neue Forschungsinfrastruktur des UFZ, bestehend aus fließseitigen mobilen Mesokosmen (MOBICOS), ermöglicht es deshalb, die Auswirkungen von Stressoren und Stressor-Kombinationen durch multifaktorielle Experimente in naturnahen Umgebungen und über anthropogene Druckgradienten zu analysieren. MOBICOS besteht aus acht containerbasierten Fließgewässerlaboren, die im Bypass zu fließenden Oberflächengewässern betrieben werden. MOBICOS kombiniert die In-situ-Echtzeit-Überwachung physikalisch-chemischer und biologischer Parameter mit manipulativen Experimenten über Bereiche von Umweltbedingungen hinweg. Innerhalb von MOBICOS können verschiedene Rinnentypen eingerichtet werden, um verschiedene Ökosystemkompartimente (pelagische, epibenthische und hyporheische Zonen) auf flexible und modulare Weise zu trennen und zu kombinieren. Aufgrund des kompakten Designs können die MOBICOS-Einheiten leicht an räumlichen Forschungsschwerpunkten verschoben werden. Darüber hinaus ermöglicht der gleichzeitige Betrieb mehrerer MOBICOS-Einheiten an verschiedenen Standorten die Integration natürlicher Gradienten in multifaktorielle Experimente. Die MOBICOS-Einheiten können also unser Verständnis der kausalen Zusammenhänge zwischen natürlichen Umweltschwankungen, anthropogenen Stressoren und ihren kombinierten ökologischen Auswirkungen auf lotische aquatische Ökosysteme über bestehende Bach-Mesokosmos-Ansätze hinaus erheblich verbessern helfen. Die Vielseitigkeit wird in der Publikation anhand zweier Fallstudien gezeigt, die sich mit (a) der hydraulischen Kontrolle von lotischen Biofilmen und (b) der durch Umweltverschmutzung verursachten Toleranz der Gemeinschaft gegenüber Biofilmen entlang eines Umweltgradienten befassen.
Publikation:
Streamside mobile mesocosms (MOBICOS): A new modular research infrastructure for hydro-ecological process studies across catchment-scale gradients; By: Fink, Patrick; Norf, Helge; Anlanger, Christine; Brauns, Mario; Kamjunke, Norbert; Risse-Buhl, Ute; Schmitt-Jansen, Mechthild; Weitere, Markus; Borchardt, Dietrich; INTERNATIONAL REVIEW OF HYDROBIOLOGY; DOI: 10.1002/iroh.201902009
Weitere Informationen finden Sie hier.
Juli 2020
 Die UFZ-Wissenschaftlerin Dr. Susanne Dunker vom Department Physiologische Diversität hat eine neuartige Methode zur Partikelanalyse für Luft- und Wasserqualitätsüberwachung, sowie zur Analyse von Pflanzen-Bestäuber-Interaktionen entwickelt, bei der Algen und Pollen, in einem hohen Durchsatz sehr schnell identifiziert und quantifiziert werden können. In der vorliegenden Arbeit beschreibt sie praktische Anwendungen und demonstriert eindrucksvoll das Potenzial dieses neuen Ansatzes.
Die UFZ-Wissenschaftlerin Dr. Susanne Dunker vom Department Physiologische Diversität hat eine neuartige Methode zur Partikelanalyse für Luft- und Wasserqualitätsüberwachung, sowie zur Analyse von Pflanzen-Bestäuber-Interaktionen entwickelt, bei der Algen und Pollen, in einem hohen Durchsatz sehr schnell identifiziert und quantifiziert werden können. In der vorliegenden Arbeit beschreibt sie praktische Anwendungen und demonstriert eindrucksvoll das Potenzial dieses neuen Ansatzes.
Über die neue Technologie
Susanne Dunker hat ein neuartiges technologische Design eines Durchflusszytometers und seine ökologischen Anwendungen zum Patent angemeldet (WO 2019/068352 A1). In Zusammenarbeit mit Informatikern entwickelt sie darüber hinaus ein Verfahren, um Methoden des maschinellen Lernens mit diesem Ansatz zu kombinieren, um eine effiziente Hochdurchsatztechnologie mit umfangreichen Dateninformationen zu etablieren. So soll diese Kombination von Technologie und Datenverarbeitung eine schnelle, automatisierte Identifizierung und Quantifizierung von Mikroorganismen erreichen. In der Biodiversitätsforschung (und darüber hinaus) können damit neue Fragen beantwortet werden, für die die bestehenden Methoden und Technologien nicht ausreichend waren. Mit Susanne Dunkers Ansatz wurde die Probenahmekapazität um Größenordnungen gesteigert - deutlich mehr Proben in kürzerer Zeit und eine viel größere taxonomische Informationsvielfalt. Es können zum Beispiel ca. 5000 Zellen pro Sekunde einzeln analysiert werden. Die Daten liefern Informationen über Zellform, Fluoreszenz (Pigmentierung) oder Lebenszyklusstadium. Kombiniert mit computergestützten Deep Learning-Methoden konnten in ersten Pilot-Studien Arten mit einer Genauigkeit von mehr als 95% identifiziert werden. Dies öffnet neue Möglichkeiten bei der Identifizierung der Pollenvielfalt, die nicht nur eine wichtige Rolle für die Luftqualität sondern auch für die Wind- und Insektenbestäubung spielt. Zukünftig ist eine Referenzbibliothek für Algen geplant, damit auch Wasserproben nun mit höherer Auflösung und Häufigkeit analysiert werden können. Auch Koexistenz- und Resilienzmechanismen von Phytoplanktonorganismen unter Umweltstress können damit zukünftig untersucht werden. Die Technologie wird darüber hinaus die Überwachung terrestrischer und aquatischer Ökosysteme erheblich voranbringen.
Anwendung der Methode für eine Fallstudie in Leipzig - Urbane Teiche als Biodiversitäts-Hotspots
Teiche sind aufgrund methodischer Limitationen ein wenig untersuchtes Forschungsobjekt. Dennoch stellen sie einen Biodiversitäts-Hotspot dar und besitzen einen hohen Wert für Ökosystemdienstleistungen wie Erholung oder Wasserrückhalt. Vor allem städtische Teiche schaffen einen direkten Kontakt für Bürger, die Natur zu erleben. Auf der anderen Seite leiden diese Systeme aber auch unter verschiedenen vom Menschen verursachten Belastungen, zum Beispiel durch hohe Nährstoffzuflüsse oder hohe Temperaturen. Phytoplanktonorganismen sind dabei ein entscheidender Teil des Ökosystems Teich und das Verständnis der Zusammensetzung der Lebensgemeinschaften ist von entscheidender Bedeutung. Besonders wenn Eutrophierung und hohe Temperaturen zur Dominanz unangenehmer toxischer Cyanobakterien führen.
Mit traditionellen mikroskopischen Methoden zur Phytoplanktonanalyse ist ein Monitoring mit hoher räumlicher Auflösung und Häufigkeit aber nicht möglich. Daher wird in der vorliegenden Publikation ein neuer Durchflusszytometrie-Ansatz zur Klassifizierung von Phytoplanktonarten, entweder in taxonomische oder morphologisch basierte funktionelle Gruppen (MBFGs), getestet. Untersucht wurde eine natürliche Phytoplanktongemeinschaft in einem städtischen Teich in Leipzig.
Die Kombination beider Klassifikationen ermöglicht dabei ein gutes mechanistisches Verständnis der Dynamik von Phytoplanktongemeinschaften. Darüber hinaus ist ein großer Vorteil der Messungen die Archivierung der mikroskopischen Bilder, die eine umfassende entsprechende Datenanalyse ermöglicht. Gezeigt werden zwei Beispiele für detaillierte Merkmals- und Bildanalysen, um einzellige Merkmale von Cyanobakterien und Chlorophyten/Euglenophyten zu untersuchen und das Schicksal einer von einer Pilzinfektion betroffenen Cyanobakterienblüte zu verfolgen.
Publikation:
Dunker, Susanne: Imaging Flow Cytometry for Phylogenetic and Morphologically Based Functional Group Clustering of a Natural Phytoplankton Community over 1 Year in an Urban Pond, CYTOMETRY PART A, DOI: 10.1002/cyto.a.24044
Weitere Informationen: Dr. Susanne Dunker ( susanne.dunker@ufz.de ), Department Physiologische Diversität
Juli 2020
 Bioelektrosynthesen können einen wesentlichen Beitrag für die zukünftige Bioökonomie leisten. Das patentierte Aufrüstset dient zur Erweiterung konventioneller Bioreaktoren, das deren Nutzung für die mikrobielle Bioelektrosynthese ermöglicht – nach der Devise: weg vom Eigenbau hin zu reproduzierbaren Forschungsbedingungen [1].
Bioelektrosynthesen können einen wesentlichen Beitrag für die zukünftige Bioökonomie leisten. Das patentierte Aufrüstset dient zur Erweiterung konventioneller Bioreaktoren, das deren Nutzung für die mikrobielle Bioelektrosynthese ermöglicht – nach der Devise: weg vom Eigenbau hin zu reproduzierbaren Forschungsbedingungen [1].
Bioelektrosynthesen als essentielle Bausteine einer erfolgreichen Bioökonomie
Die Elektrobiotechnologie deckt bereits heute ein breites Spektrum möglicher Anwendungen ab; dies beginnt bei Biobrennstoffzellen zur Reinigung von Abwasser und reicht über Biosensoren, die Entfernung von Schadstoffen aus Wasser oder Boden bis hin zur Synthese komplexer Chemikalien. Dabei kann CO2 als Rohstoff in Bioelektrosynthesen eingesetzt werden und helfen, die Ziele der „Nationalen Forschungsstrategie BioÖkonomie 2030“ zu erreichen. Bisherige Forschungen befinden sich bezüglich der verwendeten Technik allerdings noch im Anfangsstadium [2].
Mit dem Aufrüstset kann auf bereits vorhandene Bioreaktoren, dazugehörige Regelungstechnik und Peripherie zurückgegriffen werden, sodass sich Standardbioreaktoren bei Bedarf in Bioreaktoren für die Bioelektrosynthese umrüsten lassen. Dieser Schritt ist reversibel, sodass teure Doppelanschaffungen unnötig sind. Weiterhin erlaubt dieses System – im Gegensatz zu anderen Ansätzen – eine systematische Skalierung der Prozesse.
Unser Angebot
Gesucht wird ein Industriepartner (bevorzugt Hersteller von Bioreaktoren oder elektrochemischer Reaktionstechnik) zur Weiterentwicklung der bereits vorhandenen Prototypen, für eine Produktion und den Vertrieb des Aufrüstsets für Bioreaktoren für die Bioelektrosynthese.
Auf Basis heutiger vielversprechender Forschungsergebnisse möchte das UFZ gemeinsam mit seinen Partnern eine Technologie von morgen entwickeln, um damit einen wesentlichen Beitrag zu Rohstoffsicherung, Nachhaltigkeit und Klimaschutz zu leisten. Werden Sie Teil des Teams!
[1] Patente: WO2015/082490 und EP18701701
[2]
DECHEMA-Positionspapier
Weitere Informationen: Prof. Dr. Falk Harnisch (
falk.harnisch@ufz.de
), Department Umweltmikrobiologie
Juli 2020
Deutschland will seine globale Führungsrolle bei Wasserstofftechnologien sichern und hat dafür gerade eine Nationale Wasserstoffstrategie veröffentlicht. Wasserstoff bekommt damit eine zentrale Rolle bei der Weiterentwicklung und Vollendung der Energiewende, denn er ermöglicht es, mit Hilfe erneuerbarer Energien die CO2-Emissionen vor allem in Industrie und Verkehr deutlich zu verringern. Die Nutzung der Sonnenenergie für die chemische oder biologische Erzeugung von Wasserstoff ist dabei ein attraktives und umweltfreundliches technologisches Ziel, das am UFZ seit einigen Jahren im Department Solare Materialien verfolgt wird.
Stand der Technik
Die photokatalytische Wasserspaltung - die Spaltung von Wasser in Wasserstoff und Sauerstoff mittels Sonnenlicht - stellt eine technologisch wichtige Alternative zur energieaufwendigen elektrolytischen Wasserspaltung dar. Dafür werden in der Regel Algen oder Cyanobakterien eingesetzt, welche unter bestimmten Bedingungen während des Stoffwechselprozesses Wasserstoff an die Umgebung abgeben. So kann man in Algenreaktoren mittels Photosynthese Sonnenlicht direkt in Wasserstoff umwandeln. Wesentlichster Nachteil aller Techniken ist die Bildung von Knallgas, die selbst bei einer Membrantechnologie nicht die Inaktivierung eines sauerstoffsensitiven Enzymsystems und somit die Hemmung der Wasserstoffproduktion verhindern kann.
Der UFZ-Beitrag
Von den UFZ-Wissenschaftler*innen um Professor Dr. Andreas Schmid (https://www.ufz.de/soma/) wurde dafür ein grundlegender Verfahrensschritt zur späteren Herstellung von Wasserstoff entwickelt und patentiert. Durch eine zeitliche Trennung von Sauerstoffbildung und Wasserstoffproduktion umgeht das Verfahren die Bildung von explosivem Knallgas. Zugleich werden durch Nutzung der Einzelzellbiokatalyse langfristig höhere Ausbeuten möglich sein.
Das erteilte Patent stellt dabei ein wichtiges Grundlagenpatent dar, das zwar selbst noch kein fertiges Verfahren beschreibt, auf dem jedoch langfristig nachhaltige und marktfähige Verfahren für die Wasserstoffproduktion entstehen können.
Das UFZ sucht Partner, um gemeinsam in den nächsten Jahren mit dieser Technologie einen signifikanten Beitrag zur Energiewende zu leisten und zu helfen Wasserstoff als einen wichtigen und sicheren Energieträger der Zukunft zu etablieren.
Patent: DE102017104648B4: A. Schmid, A. Hoschek, B. Bühler, Verfahren zur bioreaktiven Extraktion erzeugten Sauerstoffs aus einem Reaktionsraum sowie Verwendung von phototrophen Mikroorganismen bei der Gewinnung von Wasserstoff
Weitere Informationen: Dr. Joachim Nöller (
joachim.noeller@ufz.de
), Abteilung Wissens- und Technologietransfer
 Die industrielle Synthese von C6-Monomeren für die spätere Nylonherstellung erfolgt derzeit typischerweise auf Basis der Cyclohexanoxidation bei hohen Temperaturen und großen Drücken. In diesem Prozess ist vor allem die anfängliche Oxyfunktionalisierung des Cyclohexans ein kritischer Schritt hinsichtlich der ökonomischen und ökologischen Prozesseffizienz.
Die industrielle Synthese von C6-Monomeren für die spätere Nylonherstellung erfolgt derzeit typischerweise auf Basis der Cyclohexanoxidation bei hohen Temperaturen und großen Drücken. In diesem Prozess ist vor allem die anfängliche Oxyfunktionalisierung des Cyclohexans ein kritischer Schritt hinsichtlich der ökonomischen und ökologischen Prozesseffizienz.
Daher stellt die aerobe Oxidation einer einzelnen thermodynamisch stabilen und kinetisch inerten C-H-Bindung in Cyclohexan unter nachhaltigen und umweltverträglichen Bedingungen eine große Herausforderung in der aktuellen akademischen und industriellen Forschung dar.
UFZ-Wissenschaftler*innen des Departments Solare Materialien nutzen dazu Cytochrom-P450-Monooxygenasen (Cyps), die unter milden Bedingungen wirksam die regiospezifische Oxyfunktionalisierung inerter C-H-Bindungen katalysieren. Aufgrund ihrer Cofaktorabhängigkeit und Instabilität in isolierter Form werden Oxygenasen bevorzugt in lebenden mikrobiellen Zellen eingesetzt. Pseudomonas-Stämme stellen dabei potente Wirtsorganismen für Cyps dar. Die diesbezügliche Veröffentlichung stellt die Entwicklung eines effizienten Cyp-basierten Ganzzell-Biokatalysators für die Cyclohexan-Hydroxylierung vor, wobei in einem ganzheitlichen gentechnischen Ansatz Gendosierungs-, Transkriptions- und Translationsebene berücksichtigt wurden. Pseudomonas taiwanensis VLB120 diente dabei als Wirtsstamm. Der optimierte Stamm ermöglicht eine bemerkenswerte, bisher unerreichte Hydroxylierungsaktivität von 55 Units pro Gramm Zelltrockengewicht und eine hohe Selektivität. Bei Anwendung von 5 mM Cyclohexan wurden molare Substrat- und Biomasse-spezifische Ausbeuten von 82,5% bzw. 2,46 mmol Cyclohexanol pro Gramm Biomasse erzielt. Außerdem weist er eine hohe Stabilität auf. Damit dient der Stamm nun als Ausgangspunkt für die Entwicklung neuer In-vivo-Kaskaden und Bioprozesse zur Herstellung von Polymerbausteinen wie Epsilon-Caprolacton.
Die Ergebnisse dieser Studie wurden auch in einem Vortrag der Doktorandin Lisa Schäfer auf der diesjährigen Jahrestagung der Vereinigung für Allgemeine und Angewandte Mikrobiologie (VAAM) im März in Leipzig vorgestellt (https://www.dghm-vaam.de/).
Paper: Maximizing Biocatalytic Cyclohexane Hydroxylation by Modulating Cytochrome P450 Monooxygenase Expression in P. taiwanensis VLB120, Schaefer, Lisa; Karande, Rohan; Buehler, Bruno. Front. Bioeng. Biotechnol., 2020;8:140. Published 2020 Feb 27. DOI: 10.3389/fbioe.2020.00140
Weitere Informationen: Prof. Dr. Bruno Bühler (
bruno.buehler@ufz.de
), Department Solare Materialien
 UFZ-Wissenschaftler*innen vom Department Analytische Umweltchemie präsentieren in einer Veröffentlichung eine neue und rein mechanistische COSMOperm-Methode zur Vorhersage passiver Membranpermeabilitäten für neutrale Verbindungen sowie für Anionen und Kationen. Der COSMOperm-Ansatz basiert dabei auf verbindungsspezifischen freien Energieprofilen innerhalb einer ausgewählten Membran aus COSMO-RS-Berechnungen (conductor-like screening model for realistic solvation). Eine vollständig prädiktive Berechnung der passiven Permeation durch Membranen aus Phospholipid-Doppelschichten führt zu einer Korrelation von r2 = 0,92 und rmsd = 0,90 log10 Einheiten, für neutrale Verbindungen und Anionen, im Vergleich zu Goldstandard-Experimenten mit planaren Lipidmembranen. In der Arbeit wird weiterhin gezeigt, dass neue, individuelle Membrantypen mit der verwandten COSMOplex-Methode erzeugt und von COSMOperm direkt für Permeabilitätsstudien verwendet werden können.
UFZ-Wissenschaftler*innen vom Department Analytische Umweltchemie präsentieren in einer Veröffentlichung eine neue und rein mechanistische COSMOperm-Methode zur Vorhersage passiver Membranpermeabilitäten für neutrale Verbindungen sowie für Anionen und Kationen. Der COSMOperm-Ansatz basiert dabei auf verbindungsspezifischen freien Energieprofilen innerhalb einer ausgewählten Membran aus COSMO-RS-Berechnungen (conductor-like screening model for realistic solvation). Eine vollständig prädiktive Berechnung der passiven Permeation durch Membranen aus Phospholipid-Doppelschichten führt zu einer Korrelation von r2 = 0,92 und rmsd = 0,90 log10 Einheiten, für neutrale Verbindungen und Anionen, im Vergleich zu Goldstandard-Experimenten mit planaren Lipidmembranen. In der Arbeit wird weiterhin gezeigt, dass neue, individuelle Membrantypen mit der verwandten COSMOplex-Methode erzeugt und von COSMOperm direkt für Permeabilitätsstudien verwendet werden können.
In dem zweiten Papier schlagen UFZ-Wissenschaftler*innen ein neues Modell zur Vorhersage der pH-abhängigen Basistoxizität auf der Basis von Kmem/w vor, das die Permeation sowohl neutraler als auch anionischer Spezies berücksichtigt. Für diesen Ansatz wurde das Bioakkumulationsverhalten von sechs Perfluoralkylcarbonsäuren (PFCAs), drei Perfluoralkansulfonsäuren und vier neuen Alternativen mit verschiedenen Methoden untersucht und ebenso mit der COSMO-RS-Theorie gut vorhergesagt.
Publikationen:
COSMOperm: Mechanistic Prediction of Passive Membrane Permeability for Neutral Compounds and Ions and Its pH Dependence; Schwoebel, Johannes A. H.; Ebert, Andrea; Bittermann, Kai; Huniar, Uwe; Goss, Kai-Uwe; Klamt, Andreas; J. Phys. Chem. B., DOI: 10.1021/acs.jpcb.9b11728
Membrane/Water Partitioning and Permeabilities of Perfluoroalkyl Acids and Four of their Alternatives and the Effects on Toxicokinetic Behavior; Ebert, Andrea; Allendorf, Flora; Berger, Urs; Goss, Kai-Uwe; Ulrich, Nadin; Environ. Sci. Technol., DOI: 10.1021/acs.est.0c00175
Weitere Informationen: Dr. Kai-Uwe Goss (
kai-uwe.goss@ufz.de
), Department Analytische Umweltchemie
Juni 2020
 Die mittelkettigen Fettsäuren Capron (C6)- und Caprylsäure (C8) sind wertvolle Chemikalien, die industriell bisher aus Palmkern- und Kokosöl hergestellt werden und als Additive in Schmier- oder Reinigungsmitteln, Kosmetika, Lebens- sowie Futtermittelzusätzen zum Einsatz kommen. Hierzu hat das UFZ vielversprechende und deutlich nachhaltigere Produktionswege in der Entwicklung, für die eine Demonstrationsanlage in der Planung ist.
Die mittelkettigen Fettsäuren Capron (C6)- und Caprylsäure (C8) sind wertvolle Chemikalien, die industriell bisher aus Palmkern- und Kokosöl hergestellt werden und als Additive in Schmier- oder Reinigungsmitteln, Kosmetika, Lebens- sowie Futtermittelzusätzen zum Einsatz kommen. Hierzu hat das UFZ vielversprechende und deutlich nachhaltigere Produktionswege in der Entwicklung, für die eine Demonstrationsanlage in der Planung ist.
Wissenschaftler*innen des UFZ-Departments Umweltmikrobiologie um Dr. Heike Sträuber forschen an einem anaeroben Fermentationsverfahren unter Nutzung nachwachsender Rohstoffe oder organischer Reststoffe und Abfälle, um die Fettsäuren mittels laktat-basierter mikrobieller Kettenverlängerung zu produzieren. Aufgrund der Komplexität dieses Prozesses und der Substrate werden gemischte Mikrobengemeinschaften im Bioreaktor verwendet. Es sind verschiedene Mikroorganismen bekannt, die eine mikrobielle Kettenverlängerung durchführen können. Auch laktatbildende Milchsäurebakterien spielen im Produktionsprozess eine wichtige Rolle. Aber bisher ist wenig über das Zusammenspiel zwischen säurebildenden Mikroorganismen, die an der Kettenverlängerung (von C2/C4-Säuren hin zu C6/C8-Säuren) beteiligt sind, und den Milchsäurebakterien bekannt.
In der vorliegenden Studie wurden im Langzeitversuch über 148 Tage die Dynamiken vom Stoffwechsel und der Zusammensetzung der mikrobiellen Gemeinschaft im Bioreaktor untersucht und modelliert. Dabei wurden verschiedene Produktbildungsphasen identifiziert. Anhand der Metaboliten konnte zugeordnet werden, welche Mikroorganismen in den verschiedenen Phasen dominieren. Außerdem wurde gefunden, dass in der Anfangsphase eine verstärkte Capron- und Caprylsäureproduktion auftritt, während sich in einem geschlossenen Reaktorsystem auf lange Sicht aber Butyrat (C4)-produzierende Bakterien durchsetzen.
Diese Erkenntnisse stellen einen weiteren Baustein dar, um die Capron- und Caprylsäureproduktion zu einem marktfähigen Prozess weiterzuentwickeln, der eingebettet in ein Bioraffineriekonzept einen wichtigen Beitrag zur Kreislaufwirtschaft liefern kann und werden in die Planungen für eine Demonstrationsanlage einfließen. Weitere Informationen zum gesamten Verfahren und seinen Kapazitäten können Sie gerne bei uns erhalten (
wtt@ufz.de
).
Publikation: Competition between Butyrate Fermenters and Chain-Elongating Bacteria Limits the Efficiency of Medium-Chain Carboxylate Production; Bin Liu, Sabine Kleinsteuber, Florian Centler, Hauke Harms & Heike Sträuber; Frontiers in Microbiology, Vol. 11, Art. Number 336, März 2020
Weitere Informationen: Dr. Heike Sträuber (
heike.straeuber@ufz.de
), Department Umweltmikrobiologie
Mai 2020
 Seit dem 31.12.2018 gilt in Deutschland ein neues Strahlenschutzgesetz, das einen Referenzwert für die über das Jahr gemittelte Radon-222-Aktivitätskonzentration von 300 Bq/m3 in Wohnungen, Schulen und an Arbeitsplätzen vorschreibt. In vielen Regionen Deutschlands übersteigen die Radonaktivitätskonzentrationen in der Bodenluft den Wert von 40.000 Bq/m³, sodass dort Maßnahmen zum Schutz der Bevölkerung getroffen werden müssen (BFS, 2019).
Seit dem 31.12.2018 gilt in Deutschland ein neues Strahlenschutzgesetz, das einen Referenzwert für die über das Jahr gemittelte Radon-222-Aktivitätskonzentration von 300 Bq/m3 in Wohnungen, Schulen und an Arbeitsplätzen vorschreibt. In vielen Regionen Deutschlands übersteigen die Radonaktivitätskonzentrationen in der Bodenluft den Wert von 40.000 Bq/m³, sodass dort Maßnahmen zum Schutz der Bevölkerung getroffen werden müssen (BFS, 2019).
Wissenschaftler im UFZ-Department Umweltinformatik um Prof. Dr. Holger Weiß haben bereits in Vorversuchen gezeigt, dass auch unterschiedliche meteorologische Parameter zu Schwankungen der Radonaktivitätskonzentrationen in Innenräumen beitragen (Schubert, Musolff, Weiss, 2018). Im Rahmen weiterer Vorarbeiten, die mit Hilfe des UFZ-eigenen Technologietransferfonds finanziert wurden, sind erste Feldversuche in verschiedenen Wohngebäuden im Erzgebirge durchgeführt worden. Dabei konnte nachgewiesen werden, dass über verschiedene Lüftungssteuerungen die Radonaktivitätskonzentrationen erheblich reduziert werden können (Dehnert et al., 2019). Darauf aufbauend wird nunmehr in einem ZIM-geförderten Projekt (ZIM: Zentrales Innovationsprogramm Mittelstand) ein System entwickelt, das die Radonaktivitätskonzentration als Regelparameter in dezentrale Lüftungsanlagen mit Wärmerückgewinnung und Zonensteuerung drahtlos einbindet und anhand dessen die Lüftung automatisch steuert. Partner des UFZ sind die SARAD GmbH in Dresden, die inVENTer GmbH in Löberschütz, die Bergsicherung Schneeberg GmbH & Co. KG, die Gebäude- und Wohnungsverwaltung GmbH Schlema, die Staatliche Betriebsgesellschaft für Umwelt und Landwirtschaft in Chemnitz und die sächsische Strahlenschutzbehörde LfULG in Dresden.
Literatur:
Bundesamt für Strahlenschutz (BFS) (2019): Radon-Handbuch Deutschland 2019; Schubert, M., Musolff, A., & Weiss, H. (2018): Influences of meteorological parameters on indoor radon concentrations ((222)Rn) excluding the effects of forced ventilation and radon exhalation from soil and building materials. J Environ Radioact, 192, 81-85. doi: 10.1016/j.jenvrad.2018.06.011
Online verfügbar hier
Dehnert et al. (2019): Radonschutz in Wohnungen durch radonaktivitätskonzentrationsgesteuerte Lüfter. Jahrestagung 2019 Fachverband für Strahlenschutz e.V.; Strahlenschutz und Medizin, Patienten - Beschäftigte – Gesellschaft; Würzburg, 9.-12. September 2019.
Online verfügbar hier
Weitere Informationen: Prof. Holger Weiß (
holger.weiss@ufz.de
), Department Umweltinformatik
Mai 2020
Molke ist ein Hauptnebenprodukt der Milchindustrie und für kleine und mittlere Unternehmen schwer zu nutzen und muss deshalb teuer entsorgt werden. Mikrobielle elektrochemische Technologien könnten der Schlüssel für diese Unternehmen sein, um dieses derzeitige Abfallprodukt wirtschaftlich zu verwerten.
UFZ-Wissenschaftler untersuchten eine Methode zur Entfernung von Molke aus Prozesswassern, die mit der Produktion von elektrischem Strom gekoppelt ist. In potentiostatisch-kontrollierten Halbzellenexperimenten wurden die Anoden (basierend auf einer robusten komplexen Mikrobengemeinschaft) mit einer Molkelösung mit ca. 1 g L-1 CSB gefüttert.
Mit diesem einfachen Laboransatz wurde ein durchschnittlicher Reinigungsgrad von 65,8 ± 10,9 % erzielt, gekoppelt mit einer maximalen Stromdichte von 0,31 ± 0,06 mA cm-2 und einem coulombschen Wirkungsgrad von 37,1 ± 10,8 %. Diese Werte wurden in bioelektrochemischen Reaktoren am Ende von vier Batchzyklen gemessen.
Die mikrobielle Analyse ergab eine Arbeitsteilung mit hauptsächlich planktonischen Mikroorganismen, die die komplexen Molkebestandteile durch Fermentation zu organischen Säuren abbauen, von denen ein Teil anschließend von den elektroaktiven Bakterien an der Anode zur Produktion von Strom genutzt wurde.
Auf dem Weg zu einer wirtschaftlichen Nutzung müssen aber zunächst noch weitere Untersuchungen zu mikrobiellen Struktur-Funktionsbeziehungen für eine zukünftige Prozesssteuerung durchgeführt werden, bevor man über ein Upscaling die Wirtschaftlichkeit des Verfahrens untersuchen kann.
Paper: Investigating Community Dynamics and Performance During Microbial Electrochemical Degradation of Whey; By: Esquivel, Diana Y. Alvarez; Guo, Yuting; Brown, Robert K.; et al., ChemElectroChem: Volume: 7, Issue: 4, pages: 989-997
Weitere Informationen: Prof. Falk Harnisch (
falk.harnisch@ufz.de
), Department Umweltmikrobiologie
April 2020
UFZ-Wissenschaftler berichten zusammen mit ihren Kollegen vom Helmholtz-Zentrum für Infektionsforschung – HZI und der TU Bergakademie Freiberg in der Zeitschrift Frontiers in Microbiology über einen extremophilen Bakterienstamm, Pseudomonas sp. TDA1, der in der Lage ist, einige der chemischen Bausteine des Polyurethans abzubauen. Dies könnte vielleicht ein wichtiger Schlüssel zur Wiederverwendung von schwer wiederverwertbaren Polyurethanprodukten sein.
Dabei entfielen allein im Jahr 2015 auf Polyurethanprodukte 3,5 Millionen Tonnen der in Europa hergestellten Kunststoffe. Anwendungsbereiche sind u.a. neben Kühlschränken und Gebäudeisolierungen auch Schuhe oder Möbel. Die Abfälle sind jedoch nur schwer und energieintensiv zu recyceln und landen meist auf Deponien, wo sie eine Reihe von giftigen Chemikalien freisetzen, von denen einige krebserregend sind.
Bei ihrer Genomanalyse identifizierten die Forscher Enzyme, die den Mikroben helfen, bestimmte chemische Verbindungen in Kunststoffen energetisch zu verwerten. Der Stamm gehört zu einer Gruppe von Bakterien, die für ihre Toleranz gegenüber toxischen organischen Verbindungen und anderen Formen von Stress bekannt sind, so Dr. Christian Eberlein vom Helmholtz-Zentrum für Umweltforschung – UFZ. Er ist Mitverfasser des Papiers, der die Arbeit koordiniert und überwacht hat.
Die Autoren verweisen in ihrer Arbeit aber auch darauf, dass noch mehr „grundlegendes Wissen“ wie das in der aktuellen Studie gesammelte erforderlich ist, bevor in Zukunft der Sprung in die technologische und kommerzielle Anwendung möglich wird.
Die Forschungsarbeit ist Teil eines wissenschaftlichen Programms der Europäischen Union mit dem Namen P4SB (From Plastic waste to Plastic value using Pseudomonas putida Synthetic Biology), das versucht, nützliche Mikroorganismen zu finden, die Kunststoffe auf Ölbasis in vollständig biologisch abbaubare Kunststoffe umwandeln können. Wie der Name schon sagt, konzentriert sich das Projekt auf ein Bakterium namens Pseudomonas putida.
Weitere Informationen: Dr. Hermann Heipieper (
hermann.heipieper@ufz.de
), Department Umweltbiotechnologie
April 2020
Constructed Wetlands (CWs) sind wirksame ökologische Sanierungstechnologien für verschiedene kontaminierte Gewässer. Bei Ihrer Suche nach benzolabbauenden Mikroben untersuchten UFZ-Wissenschaftler verschiedene unterirdische Strömungen eines CW, das mit benzolkontaminiertem Grundwasser gespeist wird und wurden nun fündig.
Dabei wurden zunächst relevante Mikroben durch den Einsatz von In-situ-Mikrokosmen (BACTRAPs, hergestellt aus Aktivkohlegranulat) in Verbindung mit 13C-stabiler Isotopensondierung und Illumina-Sequenzierung von 16S rRNA-Amplikons identifiziert. Dabei wurden die mit Mikroorganismen beladenen BACTRAPs 28 Tage lang gegenüber 13C-Benzol exponiert und dann der signifikante Einbau von 13C in die RNA der Bakterien nachgewiesen. Eine kürzere Inkubationszeit führte überraschenderweise nicht zu einer nachweisbaren 13C-Inkorporation.
Nach 28 Tagen waren Mitglieder von vier Gattungen, nämlich Dechloromonas, Hydrogenophaga und Zoogloea aus den Betaproteobakterien und Arcobacter aus den Epsilonproteobakterien, signifikant mit 13C markiert und in der Bakteriengemeinschaft auf den BACTRAPs reichlich vorhanden. Sequenzen, die mit Geobacter verbunden sind, waren zwar zahlreich auf den BACTRAPs nachweisbar, metabolisierten aber offenbar kein Benzol, da keine C-13-Markierung nachgewiesen wurde. Es ist jedoch möglich, dass sie pflanzliche organische Verbindungen metabolisiert haben, während sie die BACTRAPs als Elektronensenke benutzten.
In repräsentativen Gebietsproben aus den CWs waren Sequenzen, die mit Dechloromonas, Zoogloea und Hydrogenophaga verbunden sind, in relativen Anteilen von bis zu einigen Prozent vorhanden. Sequenzen, die mit Arcobacter assoziiert sind, waren dagegen in < 0,01% der Proben vorhanden.
Daraus folgerten die Wissenschaftler, dass es ihnen gelungen war, Mikroben von wahrscheinlicher Bedeutung für den Benzolabbau in einer CW, die zur Sanierung von kontaminiertem Wasser verwendet wird, zu identifizieren.
Paper: Identification of benzene-degrading Proteobacteria in a constructed wetland by employing in situ microcosms and RNA-stable isotope probing; By: Nitz, Henrike; Duarte, Marcia; Jauregui, Ruy; et al., Applied Microbiology and Biotechnology - Volume: 104, Issue: 4, Pages: 1809-1820
Weitere Informationen: Prof. Matthias Kästner (
matthias.kaestner@ufz.de
), Department Umweltbiotechnologie
April 2020
UFZ-Forscher in Magdeburg haben erfolgreich ein Visualisierungssystem für die Exploration, Analyse und Präsentation von Daten komplexer hydrologischer Studien in großen Einzugsgebieten entwickelt.
Die neuartige Visualisierung schafft ein erweitertes und tieferes Verständnis der Zusammenhänge zwischen den jeweiligen Datensätzen, ermöglicht Diskussionen zwischen Forschern aus verschiedenen Disziplinen und ist gleichzeitig eine hervorragende Grundlage für die Veranschaulichung komplexer Phänomene für Entscheider aus Behörden, Politik, Wirtschaft oder für die interessierte Öffentlichkeit.
Basierend auf dem 162.000 km² großen Einzugsgebiet des Poyang-Sees, des größten Süßwassersees Chinas, wurde eine virtuelle geographische Umgebung entwickelt, die eine Vielzahl von 2D- und 3D-Beobachtungsdatensätzen mit Simulationsergebnissen sowohl aus einem OpenGeoSys-Grundwassermodell als auch aus einem hydrodynamischen COAST2D-Modell kombiniert, das die Wasser- und Stoffdynamik innerhalb und zwischen hydrologischen Reservoiren visualisiert. Das System zielt auf eine realistische Darstellung des Untersuchungsgebietes ab und implementiert Ansätze der wissenschaftlichen Visualisierung, um interessante Aspekte von multivariaten Daten auf intuitive Weise zu veranschaulichen. Zudem verwendet es leicht zu erlernende Interaktionstechniken für die Navigation, die Animation und den Zugang zu verknüpften Datensätzen aus externen Quellen, wie Zeitreihendaten oder Websites, um als Umweltinformationssystem für jede beliebige Region zu fungieren.
Paper: A virtual geographic environment for multi-compartment water and solute dynamics in large catchments
By: Rink, Karsten; Nixdorf, Erik; Zhou, Chengzi; et al., Journal of Hydrology: Volume: 582, Article Number: 124507
Weitere Informationen: Dr. Karsten Rink (
karsten.rink@ufz.de
), Department Umweltinformatik
April 2020
Im Rahmen der Frühjahrstagung der Biotechnologen hat sich der Lenkungskreis der DECHEMA-Fachgemeinschaft Biotechnologie neu konstituiert. Professor Dr. Andreas Schmid vom UFZ (Department Solare Materialien) wurde von der Mitgliederversammlung als Mitglied reingewählt. An der Spitze des Gremiums steht zukünftig Prof. Dr. Andreas Liese, TU Hamburg.
Mit über 1.800 Mitgliedern bietet die DECHEMA-Fachgemeinschaft Biotechnologie Fachleuten aus akademischer Forschung und Industrie ein Forum für Kooperationen und Austausch. Die Themenspanne reicht von der Algenbiotechnologie über die Bioprozesstechnik bis zu synthetischer Biologie und Zellkulturtechnik. Der Lenkungskreis der DECHEMA-Fachgemeinschaft Biotechnologie ist für die Koordinierung der Aktivitäten und für das Portfolio an Gremien innerhalb der Fachgemeinschaft zuständig. Darüber hinaus entwickelt das Gremium Vorschläge für strategische Initiativen, bearbeitet gremienübergreifende Themen und pflegt den Kontakt zu anderen Organisationen. Die Mitglieder des Lenkungskreises werden jeweils für drei Jahre gewählt.
Quelle: Presseinformation der DECHEMA vom 03.03.2020
Weitere Informationen: Prof. Andreas Schmid (
andreas.schmid@ufz.de
), Department Solare Materialien
März 2020
Industriepartner für UFZ-Forscher: erfolgreiches „Speeddating“ auf der European Chemistry Partnering
 Abteilung Wissens- & Technologietransfer stellt UFZ-Forschung vor und vermittelt Themen und Kontakte
Abteilung Wissens- & Technologietransfer stellt UFZ-Forschung vor und vermittelt Themen und Kontakte
Die European Chemistry Partnering in Frankfurt am Main ist eine wichtige Kontaktbörse für die Chemiebranche in Deutschland und darüber hinaus. Für das UFZ wiederum ist der Sektor ein bedeutender Partner in Bezug auf die Entwicklung und tatsächliche Anwendung umweltfreundlicherer Prozesse und Produkte sowie die Vermeidung oder Beseitigung von Umweltschäden durch bereits existierende Verfahren.
Vor diesem Hintergrund nahmen Vertreter der Abteilung Wissens- und Technologietransfer (WTT) am 27.02.2020 an 20-minütigen Eins-zu-eins-Gesprächen im Stil eines „Speeddatings“ teil.
Ausgewählte Themen und Forschungsarbeiten aus dem Themenbereich „Umwelt- und Biotechnologie“ wurden dabei vorgestellt und gemeinsame Interessen herausgearbeitet. Im Nachgang wurden zu fast allen Gesprächen weitere Informationen ausgetauscht und Kontakte zu UFZ-Wissenschaftlern vermittelt, so dass dieser erste Versuch mit dem genannten „Partnering“-Format als erfolgreich bewertet und sicherlich zu gegebener Zeit wiederholt wird.
Weitere Informationen: Dr. Lydia Woiterski (
lydia.woiterski@ufz.de
), Abteilung Wissens- und Technologietransfer
März 2020
 Unter dem Titel "Dürren in Mitteldeutschland - Auswirkungen, Herausforderungen, Anpassungsoptionen“ trafen sich am 14./15. Januar rund 150 Teilnehmer am UFZ. Das UFZ lud Teilnehmer*innen aus Wissenschaft, Praxis sowie Politik und Verwaltung nach Leipzig ein, um die Folgen der vergangenen Dürren für Land- und Forstwirtschaft zu diskutieren. Gemeinsam wurde auch überlegt, wie sich Landwirte und Waldbesitzer in Zukunft an die veränderten Klimakonditionen anpassen können und welchen Input die Wissenschaft dafür liefern kann.
Unter dem Titel "Dürren in Mitteldeutschland - Auswirkungen, Herausforderungen, Anpassungsoptionen“ trafen sich am 14./15. Januar rund 150 Teilnehmer am UFZ. Das UFZ lud Teilnehmer*innen aus Wissenschaft, Praxis sowie Politik und Verwaltung nach Leipzig ein, um die Folgen der vergangenen Dürren für Land- und Forstwirtschaft zu diskutieren. Gemeinsam wurde auch überlegt, wie sich Landwirte und Waldbesitzer in Zukunft an die veränderten Klimakonditionen anpassen können und welchen Input die Wissenschaft dafür liefern kann.
Nachfolgend werden die konkreten Ergebnisse und Forderungen zusammengefasst.
Die Folgen der Düre 2018/2019
Diese Jahre waren in Deutschland insgesamt deutlich wärmer als im langjährigen Mittel bei gleichzeitig unterdurchschnittlichen Niederschlagsmengen. Beides führte zu einer langanhaltenden, extremen Dürre. Die Folgen waren u.a. Ertragseinbußen in der Landwirtschaft, Trockenschäden und Schädlingsbefall in den Wäldern sowie negative Auswirkungen für die Schifffahrt, die Energiewirtschaft sowie den Tourismus. Zudem kam es 2018 vermehrt zu Flächen- und Waldbränden. Die Bodentrockenheit hat vielerorts zu sehr niedrigen Grundwasserneubildungsraten geführt, deren längerfristige Auswirkungen bisher nicht absehbar sind.
Werden Dürreereignisse in Zukunft häufiger?
Die Wahrscheinlichkeit von Hitzewellen, wie im Juli 2019 in Deutschland, hat sich im Durchschnitt ungefähr verzehnfacht. Zahlreiche Forschungsarbeiten haben gezeigt, dass diese in Zukunft sowohl häufiger als auch intensiver eintreten werden. Mit der zukünftigen Erwärmung geht auch eine Verlängerung der Zeit unter Dürre in Deutschland einher.
Politischer Handlungsbedarf
Derzeit unterstützten Bund und Länder die Land- und Forstwirtschaft vor allem bei der Kompensation der schlimmsten finanziellen Folgen (z.B. Dürrehilfe). Es bedarf aber eines stärker integrierten und vorausschauenden Politikansatzes der Länder und des Bundes. Dieser beinhaltet u.a. die folgenden Punkte:
• Die koordinierte und umfassende Abschätzung zukünftiger Dürrerisiken (z.B. für die Land-, Forst- und Wasserwirtschaft, aber auch für Ökosysteme und deren Leistungen);
• Die Entwicklung von politischen Rahmenbedingungen, die gezielt nachhaltige und klimaresiliente Innovationen in der Land-, Forst-, und Wasserwirtschaft fördern (Dürrerisikomanagement);
• Eine regelmäßige Überprüfung und Aktualisierung der Risikobewertung und der Managementansätze (Monitoring und Evaluation).
Forschungsbedarf
Dürren sind Risiken, die sich negativ auf Pflanzen- und Tierarten, Ökosysteme und Gesellschaft auswirken. Daher bedarf es einer integrierten Dürreforschung, die verschiedene Disziplinen aus den Natur- und Sozialwissenschaften vereinigt.
So gilt es zum Beispiel eine trans- und interdisziplinäre Dürreforschung aufzubauen, mit dem Ziel Dürrerisiken sektoral umfassend und auf verschiedenen Skalen zu bewerten sowie nachhaltige und klimaresiliente Anpassungsmaßnahmen und -strategien zu entwickeln.
Wichtig wäre auch der Aufbau einer Datenbank zu den Folgen von Dürren. Die Datenbank müsste multisektoral angelegt sein und könnte sich an der Datenbank des European Drought Impact Report Inventory (EDII) bzw. European Drought Reference (EDR) orientieren.
Die Konferenz im Januar 2020 wurde als Teil der Helmholtz-Klimainitiative und des Projekts CLIMALERT getragen, das über das Bundesministerium für Bildung und Forschung im Rahmen der European Research Area for Climate Services (ERA4CS, http://climalert.eu) finanziert wird. Organisiert wurde die Veranstaltung vom UFZ-Department Stadt- und Umweltsoziologie und vom Mitteldeutschen Klimabüro am UFZ.
Weiter Informationen: Prof. Christian Kuhlicke (
christian.kuhlicke@ufz.de
), Department Stadt- und Umweltsoziologie
Februar 2020
 Tappbodetalsperre im Ostharz; Foto André Künzelmann, UFZ
Tappbodetalsperre im Ostharz; Foto André Künzelmann, UFZ
Das UFZ betreibt an der Rappbode-Talsperre im Harz, der größten Trinkwassertalsperre Deutschlands, eine einmalige Monitoring-Infrastruktur: Das Talsperrenobservatorium Rappbode (TOR). Das TOR wurde 2011 im Rahmen vom TERENO-Projekt (Link) aufgebaut und beinhaltet 8 online-Monitoringstationen zur Wasserqualität. Als Besonderheit des TOR gilt die detaillierte Überwachung der Zuflüsse in die Talsperre, andere Standgewässer-Monitoringaktivitäten in der deutschen und internationalen Forschungslandschaft fokussieren lediglich das Standgewässer und vernachlässigen die Zuflüsse. Hierdurch kann im TOR die Verbindung zwischen Einzugsgebiet und Gewässer aufgelöst werden – ein ausgesprochen wichtiger Antriebsfaktor für die Wassergüteentwicklung von Talsperren.
Von Beginn an war der Talsperrenbetrieb Sachsen-Anhalt (TSB) in das Projekt integriert, stellte Platz und Zugang zu Gewässern und Elektrizität zur Verfügung. Diese Zusammenarbeit wurde im Rahmen des BMBF-Projektes TALKO intensiviert, bei dem die Einträge von gelösten organischen Kohlenstoff (DOC) in das Gewässer untersucht wurden und Prognosen zur Entwicklung der DOC-Frachten erstellt wurden. Durch merklich ansteigende Konzentrationen wurde der Gehalt an DOC zur wichtigsten Wasserqualitätsdeterminante der Talsperre mit deutlichen negativen Auswirkungen auf die Trinkwasseraufbereitung durch die Fernwasserversorgung Elbaue-Ostharz GmbH (FWV). Die Spielräume im Talsperrenmanagement zur Minimierung der DOC-Einträge sind äußerst begrenzt und erfordern eine adaptive Steuerung der Wasserüberleitungen in die Rappbode-Talsperre aus dem Bodesystem (durch Steuerung der Überleitungssperre Königshütte). An diesem Punkt zahlte sich der Betrieb des TOR auch in der wasserwirtschaftlichen Praxis für den TSB und die FWV aus. Das UFZ organisierte eine automatische Weiterleitung der online-Daten in die Datenhaltungen des TSB und der FWV und das TOR wurde Bestandteil des operativen Managements.
Im Sommer 2019 wurde deutlich, dass eine Erneuerung der Sensorik unausweichlich ist. Der TSB hat in unkomplizierter Weise die Kosten dafür direkt übernommen und somit nicht nur eine Erneuerung des TOR finanziert, sondern auch den Betrieb des Observatoriums für viele weitere Jahre sichergestellt. Das TOR wird weiterhin gemeinsam betrieben und die Messdaten stehen Forschung und Praxis gleichermaßen zur Verfügung. Seit Etablierung sind 30 internationale Publikationen im Kontext des TOR erschienen.
Weitere Informationen zu TOR
Februar 2020
Oman ist einer der Staaten dieser Welt, die zukünftig noch verstärkter mit Wasserknappheit zu kämpfen haben werden. Wasserknappheit wird größtenteils durch eine ungünstige Verteilung sowie Verschmutzung von Wasserressourcen verursacht. Deshalb spielt die Abwasserbehandlung eine Schlüsselrolle bei der Bekämpfung von Wasserknappheit. Ziel ist es, lokale Wasserkreisläufe zu schließen und durch eine sichere Sammlung und Behandlung Wasserverschmutzung zu vermeiden. Zugleich wird dabei aufbereitetes Wasser zur Wiederverwendung bereitgestellt. Deshalb ist ein Schwerpunkt des Institute of Advanced Technology Integration (IATI) im Oman neue Lösungen dafür zu entwickeln und wird dabei vom UFZ unterstützt.
Verbesserung einer bewährten Technologie
In Zusammenarbeit mit dem Research Council (TRC) des Omans und dem Department Umwelt- und Biotechnologisches Zentrum (UBZ) am UFZ entwickelten die Wissenschaftlerinnen und Wissenschaftler ein innovatives System zur integrierten Abwasserbehandlung und -verwertung. Es wurde unter dem Titel “A multi-functional cover layer unit for aerated wastewater treatment wetlands with integrated freshwater production and land recovery for recreational use and crop cultivation” im Oman zum Gebrauchsmuster (OM/P/2019/000412) angemeldet. Dagegen haben herkömmliche Abwasserbehandlungssysteme, wie z.B. belüftete Pflanzenkläranlagen (ACWs) nach den deutschen Konstruktionsrichtlinien (DWA, 2017) haben einen relativ großen Flächenbedarf. In warmen Klimazonen wie dem Oman und den Nachbarländern führt eine derart große Fläche zu hohen Wasserverlusten (durch Evapotranspiration) und kann somit die Funktion dieser Feuchtgebiete beeinträchtigen, da die Hydrologie der wichtigste Konstruktionsfaktor ist. Der neue technologische Ansatz behebt diesen Nachteil und erlaubt die Erzeugung von hochwertig behandeltem Wasser, das der strengsten Behandlungsklasse entspricht, d.h. 95% Entfernung des BSB5, 90% Entfernung des Gesamt-P und 90% Nitrifikation. Solch aufbereitetes Wasser eignet sich für die landwirtschaftliche Bewässerung und den Hausgebrauch, insbesondere in Trockengebieten und wasserarmen Ländern.
Innovationspreis und Pilotanlage
Shamsa Al Saadi vom IATI, Oman, die am UFZ promovierte, wurde für ihre hervorragende Lösungsansätze mit dem dritten Platz in der Kategorie „Innovation“ beim Water Research and Innovation Award Forum 2019 in Oman ausgezeichnet. Das entwickelte System wurde am deutschen Demonstrationsstandort im BDZ (Bildungs- und Demonstrationszentrum Dezentrale Infrastruktur) in Leipzig untersucht und soll nun als Pilotanlage im technischen Maßstab im Oman implementiert werden.
Kontakt
Dr. Manfred van Afferden (
manfred.afferden@ufz.de
), Department Umwelt- und Biotechnologisches Zentrum
Januar 2020
 UFZ Research Prize Awardees 2019
UFZ Research Prize Awardees 2019
© Klaus-Dieter Sonntag
Der Ökotoxikologe Prof. Dr. Rolf Altenburger und das Team des EU-Projekts SOLUTIONS unter der Leitung von PD Dr. Werner Brack erhielten den mit 10.000 Euro dotierten Forschungspreis 2019 des Helmholtz-Zentrums für Umweltforschung (UFZ).
Prof. Altenburger, Leiter des Departments Bioanalytische Ökotoxikologie (BIOTOX), untersucht seit mehreren Jahrzehnten Mischungen von Chemikalien. Obwohl die Konzentrationen einzelner Schadstoffe im Laufe der Jahre abnahmen, bringt der Mensch immer wieder neue Chemikalien mit neuen Eigenschaften und unerwarteten Wirkungen in die Umwelt ein, was seine Forschung nach wie vor unverzichtbar macht. Er ist nicht nur ein ausgezeichneter Wissenschaftler, sondern bringt auch interdisziplinäre Experten zusammen, fungiert als Berater und regt den Wissenstransfer mit Interessenvertretern und Behörden wie dem Umweltbundesamt, europäischen wissenschaftlichen Kommitees oder der Gemeinsamen Forschungsstelle der EU-Kommission an und trägt mit seiner Forschung zur Regulierung von Chemikalien auf nationaler und internationaler Ebene bei.
Zweiter Preisträger ist das Team des von der Europäischen Kommission mit 12 Millionen Euro geförderten Projekts SOLUTIONS. Ein Konsortium von 39 Kooperationspartnern (unter Beteiligung der UFZ-Departments Wirkungsorientierte Analytik, Ökologische Chemie, Zelltoxikologie und BIOTOX) aus 17 Ländern arbeitete zusammen mit Anwendern aus Politik und Behörden an Lösungen (SOLUTIONS) für gegenwärtige und zukünftige aufkommende Schadstoffe im Land- und Wasserressourcenmanagement. Die Überwachung einzelner Schadstoffe in Gewässern reicht heutzutage nicht aus. Daher konzentrierte sich dieses Projekt auf die Überwachung komplexer chemischer Gemische und deren Abbauprodukten sowie die Bewertung des Risikopotentials für Umwelt und Mensch. Neu entwickelte Überwachungsinstrumente, -modelle und -methoden wurden in Fallstudien erfolgreich erprobt. Schließlich wurden neue Ansätze zur Risikobeurteilung und zur Reduktion der Schadstoffbelastung in Empfehlungen und Policy Briefs umgesetzt, um die Europäische Wasserrahmenrichtlinie zu verbessern.
Weitere Informationen
Kontakt
Prof. Rolf Altenburger (
rolf.altenburger@ufz.de
), Leiter des Department Bioanalytische Ökotoxikologie
PD Dr. Werner Brack (
werner.brack@ufz.de
), Leiter des Department Wirkungsorientierte Analytik
Januar 2020
 Zum sechsten Mal wurden im Herbst 2019 die UFZ-Preise vergeben. Jährlich ehrt das UFZ mit diesen Preisen herausragende Leistungen von UFZ-Mitarbeiter*innen und deren besonderes Engagement für das UFZ.
Zum sechsten Mal wurden im Herbst 2019 die UFZ-Preise vergeben. Jährlich ehrt das UFZ mit diesen Preisen herausragende Leistungen von UFZ-Mitarbeiter*innen und deren besonderes Engagement für das UFZ.
In einer festlichen Veranstaltung wurden unter anderen der UFZ-Technologietransferpreis und UFZ-Wissenstransferpreis an folgende Wissenschaftler*innen überreicht.
Dr. Susanne Dunker (Department Physiologische Diversität) bekam den UFZ-Technologietransferpreis 2019 für ihre Forschungs- und Entwicklungsarbeiten zur Hochdurchsatzanalytik für ökologische Proben mit bildgebender Durchflusszytometrie.
Einem Team von Wissenschaftler*innen bestehend aus Dr. Christiane Schulz-Zunkel und Mathias Scholz (Department Naturschutzforschung) sowie Dr. Mario Brauns und Prof. Dr. Markus Weitere (Department Fließgewässerökologie) wurden mit dem UFZ-Wissenstransferpreis 2019 ausgezeichnet. Das Team hat im Projekt „Wilde Mulde“ umfangreiche transdisziplinäre Grundlagen geschaffen, mit denen lange Abschnitte großer mitteleuropäischer Flüsse erfolgreich renaturiert werden können.
Januar 2020
